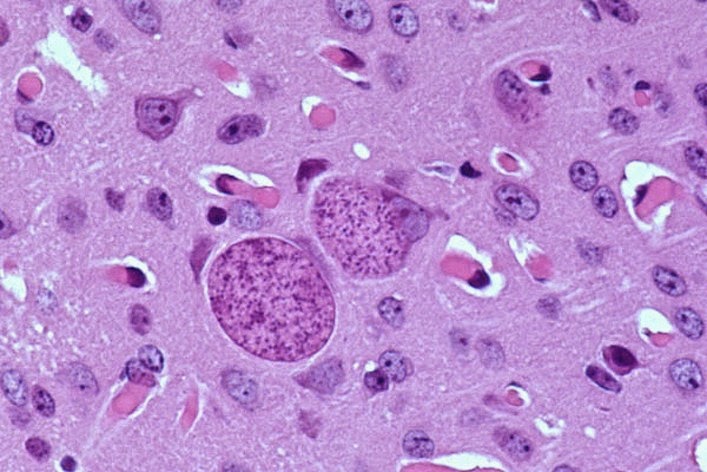

Toxoplasma gondii, IgG (количественно)
Токсоплазмоз – паразитарное заболевание, вызываемое представителем простейших токсоплазмой гондии. Наибольшую опасность оно представляет для беременных женщин, так как может привести к аномалиям развития плода и даже к его смерти.
Синонимы русские
Антитела класса IgG к токсоплазме гондии.
Синонимы английские
Antitoxo-IgG, toxoplasma gondii Antibodies, IgG, toxoplasmosis antibodies, IgG.
Метод исследования
Твердофазный хемилюминесцентный иммуноферментный анализ («сэндвич»-метод).
Единицы измерения
МЕ/мл (международная единица на миллилитр).
Какой биоматериал можно использовать для исследования?
Венозную кровь.
Как правильно подготовиться к исследованию?
Не курить в течение 30 минут до исследования.
Общая информация об исследовании
Т.
У большинства здоровых людей данная инфекция не вызывает никаких проявлений или протекает в форме легких гриппоподобных заболеваний. У плода, заразившегося от матери, или у человека с ослабленной иммунной системой т. гондии может приводить к тяжелым осложнениям.
Т. гондии очень распространена. Она встречается во всем мире, а в некоторых странах инфицировано до 95 % населения. По данным ВОЗ, около 23 % людей старше 12 лет страдают токсоплазмозом. Заражение происходит при употреблении загрязненной пищи (особенно плохо приготовленного мяса) или воды, а также при уборке помета кошки, при передаче инфекции от матери к ребенку и в редких случаях во время трансплантации органов или переливания крови.
Окончательными хозяевами для т. гондии являются дикие и домашние кошки. После того как кошки заражаются, употребляя в пищу инфицированных птиц, грызунов или сырое мясо, т.
Первичное или повторное заражение т. гондии приводит к выраженным симптомам заболевания у людей с ослабленной иммунной системой, например у больных ВИЧ/СПИДом, проходящих курсы химиотерапии, пациентов после трансплантации органов или принимающих иммунодепрессанты. Могут поражаться глаза и нервная система, что вызывает головные боли, судороги, спутанность сознания, лихорадку, энцефалит, потерю координации и затуманенность зрения.
Когда заражается беременная женщина, вероятность того, что инфекция передастся будущему ребенку, составляет 30-40 %. Причем, если инфицирование происходит в начале беременности, оно может вызывать выкидыши, мертворождения или приводить к серьезным осложнениям у новорождённых, в том числе умственной отсталости, судорогам, слепоте и увеличению печени или селезенки. Многие инфицированные дети, особенно те, кто заразился ближе к появлению на свет, рождаются здоровыми, но спустя несколько лет у них развиваются тяжелые инфекции глаз, потеря слуха и задержка умственного развития.
Когда происходит контакт человека с т. гондии, его иммунная система реагирует, вырабатывая антитела против паразита. В крови может быть обнаружено два вида антител к токсолплазме: IgM и IgG.
Антитела IgG вырабатываются организмом через несколько недель после первичного инфицирования, чтобы обеспечить долгосрочную защиту. Уровень IgG нарастает во время активности инфекции, а затем стабилизируется, как только заболевание проходит и паразит становится неактивным. Однажды столкнувшись с т. гондии, человек на протяжении всей жизни будет иметь некоторые измеряемые количества антител IgG в крови.
Однажды столкнувшись с т. гондии, человек на протяжении всей жизни будет иметь некоторые измеряемые количества антител IgG в крови.
Данный тест может быть использован, наряду с анализом на IgM, чтобы помочь подтвердить наличие острого или прошедшего инфицирования токсоплазмой.
Для чего используется исследование?
- Чтобы определить, была ли инфицированна т. гондии женщина, планирующая беременность, и есть ли у нее иммунитет к данной инфекции. Во время беременности исследование необходимо, если подозревается возможное заражение.
- Для выявления инфекции у людей с ослабленным иммунитетом, у которых подозревается токсоплазмоз, или у тех, у кого есть его выраженные симптомы.
Когда назначается исследование?
- При симптомах токсоплазмоза.
- Если пациент контактировал с кошачьими экскрементами, сырым (плохо приготовленным) мясом или зараженной водой.
- Если врач хочет определить, был ли у женщины ранее токсоплазмоз.

- На этапе подготовки к беременности для определения напряженности иммунитета к данной инфекции.
- При симптомах гриппоподобных заболеваний у людей с ослабленной иммунной системой.
Что означают результаты?
Референсные значения
Результат: отрицательный.
|
Отрицательный результат |
|
|
Сомнительный результат |
> 1 — |
|
Положительный результат |
> 3 МЕ/мл (либо равно 3) |
Причины положительного результата:
- активизация скрытой инфекции и/или хронической инфекции,
- текущая или ранее перенесенная инфекция.
Причины отрицательного результата:
- отсутствие инфицирования возбудителем в прошлом – если нет симптомов токсоплазмоза.
При подозрении на заражение исследование рекомендуется повторить через 10-14 дней, так как при первичном инфицировании антитела могут просто не успеть выработаться иммунной системой.
Анализ крови на таксоплазму ᐈ (Toxoplasma gondii), антитела IgМ
Описание анализа:
Токсоплазма (Toxoplasma gondii), антитела IgM – обследование, предназначенное выявить в крови иммуноглобулины М к токсоплазме – микроскопическому паразиту, относящемуся к простейшим. Токсоплазмоз, спровоцированный этим возбудителем, — одна из самых распространенных в мире паразитарных инвазий. В некоторых странах инфицирование токсоплазмой может быть практически поголовным, а средняя цифра по планете составляет около 20%.
Основной переносчик болезни к человеку – кошки, через которых паразит чаще всего и попадает в человеческий организм. От человека к человеку он передается только путем внутриутробного заражения (от матери к ребенку).
Иммунная система здорового человека быстро реагирует на паразита и часто этот процесс происходит без ощутимых симптомов или с незначительными симптомами, напоминающими легкую простуду. Ярко проявляется болезнь лишь у людей с ослабленным иммунитетом, у которых токсоплазмоз может вызывать головные боли, затуманенность зрения, проблемы с координацией, лихорадку и спутанность сознания.
Но наибольшую опасность токсоплазмоз несет для беременных женщин и их плода, имея способность вызывать самопроизвольное прекращение беременности и тяжелые пороки развития у ребенка. Потому анализ на токсоплазму всегда включается в пакет исследования на TORCH-инфекции, на которые обследуются беременные или планирующие беременность женщины.
В ответ на инфекцию организм вырабатывает антитела двух классов — иммуноглобулины M и G. Именно IgM являются первой реакцией организма на паразита и маркером протекания в организме острого токсоплазмоза.
Показания к назначению анализа на антитела IgМ к токсоплазме
Анализ необходим всем без исключения беременным, даже если у них никогда не было симптомов токсоплазмоза, потому обследование входит в комплекс анализов на TORCH-инфекции и часто назначается гинекологами. Кроме того, обследование может быть назначено терапевтом, педиатром или инфекционистом.
Кроме того, обследование может быть назначено терапевтом, педиатром или инфекционистом.
Показания к назначению в гинекологии:
- планирование беременности;
- проявления токсоплазмоза во время вынашивания ребенка.
Показания к назначению в остальных случаях:
- симптомы токсоплазмоза.
Интерпретация полученных результатов
Если полученные результаты анализа на IgM к токсоплазме менее 0,9 значит анализ негативный: антител не выявлено, а пациент не болел токсоплазмозом, как минимум, в ближайшее время.
Значения индекса позитивности в пределах 0,9-1,09 говорят о сомнительном результате и о том, что анализ необходимо повторить спустя несколько дней.
Если полученный результат составил 1,1 и выше – анализ положительный, а у пациента в данный момент протекает токсоплазмоз.
Подготовка к обследованию: в подготовке необходимости нет. Если пациент курит – в день забора крови желательно воздержаться от курения.
Если пациент курит – в день забора крови желательно воздержаться от курения.
Материал исследования: венозная кровь.
Метод исследования: ИФА (иммуноферментный анализ).
Сроки готовности результата: 2 рабочих дня.
Четыре новые опасные инфекции, передающиеся половым путем
- Брюн Нельсон
- Mosaic*
Автор фото, iStock
Підпис до фото,Ученые обеспокоены появлением новых опасных заболеваний, передающихся половым путем
Постоянно появляются новые болезни, и заболевания, передающиеся половым путем (ЗППП) — не исключение.
Мы расскажем вам о четырех типах бактерий, которые являются возбудителями новых опасных ЗППП и серьезно угрожают здоровью человека.
1. Менингококк
Бактерии Neisseria meningitidis вызывают менингококковую инфекцию, которая может привести к смертельно опасному поражению слизистой оболочки носоглотки, а также оболочек головного и спинного мозга.
Ранее менингококковую инфекцию преимущественно связывали с менингитом — воспалением оболочки головного мозга, нередко с летальным исходом.
Однако сегодня ее все чаще относят к урогенитальному типу инфекций.
В одном из исследований 1970-х годов был описан случай аутофелляции у шимпанзе — переноса бактерий менингококка из ротовой полости на половой член.
Носителями инфекции являются 5-10% взрослых. Обычно бактерии Neisseria meningitidis живут на слизистой носоглотки человека. Бактерии, как отмечают врачи, передаются во время орального секса.
Вспышки этого заболевания регистрируют в Европе, Канаде и США. Как правило, носителями инфекции оказываются геи и бисексуалы.
Близким родственником Neisseria meningitidis является возбудитель гонореи — Neisseria gonorrhoeae. В 2015 году в США был выделен штамм Neisseria, что является результатом генетической рекомбинации ДНК обеих бактерий. Этот тип инфекции вызвал вспышку заболевания сразу в нескольких городах США в 2015 году.
Одно из исследований изучает случаи воспаления мочеиспускательного канала, вызванного менингококковой бактерией. Речь шла о конкретной группе мужчин. По предположению ученых, инфекция передалась во время орального секса.
Ученые определили, что ДНК штамма, вызвавшего вспышку заболевания сразу в нескольких городах США в 2015 году, сформировалась путем генетической рекомбинации с подобной инфекцией — гонококком, который является возбудителем гонореи.
Этот штамм отличается повышенной контагиозностью, то есть быстрее других распространяется среди людей.
Пять типов Neisseria meningitidis вызывают большую часть случаев заболеваний по всему миру. К счастью, существует две вакцины, которые эффективно действуют против всех пяти типов бактерии.
2. Микоплазма гениталиум
Микоплазма гениталиум (Mycoplasma genitalium) — одна из самых маленьких по размеру бактерий, однако вызванные ею болезни относят к самым опасным инфекциям, передающимся половым путем.
Об этой бактерии стало известно в 1980-х годах. Сейчас ее носителями являются 1-2% жителей планеты — в основном подростки и молодые люди.
Автор фото, iStock
Підпис до фото,Инфицирование mycoplasma genitalium может напоминать хламидиоз. Эта инфекция особенно опасна для здоровья женщин
Чаще всего заражение протекает бессимптомно, либо могут возникать симптомы, характерные для гонореи или хламидиоза — воспаление шейки матки или мочеиспускательного канала.
У женщин эта инфекция может спровоцировать воспаление органов малого таза, последствия заражения могут быть довольно серьезными — в частности бесплодие, выкидыш, преждевременные роды и замершая беременность, когда плод умирает в теле матери.
Хотя презервативы и защищают от этой инфекции, врачи обеспокоены тем, что бактерии mycoplasma genitalium активно развивают устойчивость к антибиотикам — таким как азитромицин и доксициклин.
«Меня беспокоит то, что этот микроорганизм производит все большую устойчивость [против действия антибиотиков], и инфекция становится все более распространенной», — говорит Мэтью Голден, директор программы по борьбе с ВИЧ и ЗППП в Сиэтле и округе Кинг.
Своевременная диагностика и раннее лечение, как надеются ученые, помогут предотвратить превращение бактерий Mycoplasma genitalium в супербактерии.
3. Шигелла Флекснера
Шигеллезы — группа заболеваний, вызванная бактериями рода Shigella, с фекально-оральным механизмом передачи.
Результатом заражения Shigella flexneri становится дизентерия, которая вызывает сильные желудочные спазмы и диарею с примесью крови и слизи.
Автор фото, iStock
Підпис до фото,Результатом заражения Shigella flexneri становится дизентерия, которая вызывает сильные желудочные спазмы и диарею
Ранее считалось, что этому заболеванию больше подвержены дети и путешественники, отправляющиеся в бедные страны.
Однако с 1970-х годов случаи шигеллеза стали все чаще регистрировать и среди геев и бисексуалов.
По предположению ученых, в этих случаях бактерия передается во время анального и орального секса. С появлением нового пути распространения инфекции были зафиксированы вспышки заболевания по всему миру.
С появлением нового пути распространения инфекции были зафиксированы вспышки заболевания по всему миру.
Деметр Даскалакис, представитель Департамента здравоохранения Нью-Йорка, говорит, что это заболевание, передающееся половым путем, также становится устойчивым к антибиотикам — в частности к азитромицину, который применяют и для лечения гонореи.
4. Венерическая лимфогранулема (ВЛГ)
Это заболевание вызывают редкие штаммы бактерий Chlamydia trachomatis, говорит Кристофер Шиссль, врач клиники One Medical в Сан-Франциско.
Автор фото, Science Photo Library
Підпис до фото,Опасность заключается в том, что возбудители новых заболеваний быстро развивают устойчивость к существующим антибиотикам
При заражении сначала появляются нарывы и язвы в области гениталий, потом инфекция проникает в лимфатическую систему человека.
Болезнь может напоминать воспаление кишечника и привести к хроническим и значительным нарушениям его работы — например, к образованию свищей или сужению кишечника.
За последние 10 лет венерическая лимфогранулема стала довольно распространенным заболеванием в странах Европы и Северной Америки. Как правило, заболевание диагностируют у геев и бисексуалов.
Как и в случае с хламидиозом, это заболевание повышает риск заражения ВИЧ.
По словам врачей, использование презервативов снижает риск заражения этой инфекцией. Лечение ВЛГ предусматривает прием антибиотиков (например, доксициклина) в течение трех недель.
Які хвороби переносять домашні тварини
ВООЗ зазначає, що у 99% захворювань джерелом вірусу сказу були собаки. Натомість, домашні кішки найчастіше стають причиною токсоплазмозу, який дуже небезпечний для вагітних. Які хвороби передаються від тварин до людей та як вберегтися від них, маючи домашнього улюбленця, читайте далі.
Домашні тварини стали частиною життя багатьох людей. Вони допомагають побороти самотність, покращити настрій. Існує навіть окремий вид терапії, так звана, пет-терапія. Це індивідуальна або групова активність, до якої залучають тварин для покращення самопочуття пацієнтів. Детальніше тут:https://bit.ly/2P4rsO3
Це індивідуальна або групова активність, до якої залучають тварин для покращення самопочуття пацієнтів. Детальніше тут:https://bit.ly/2P4rsO3
Проте через необачне ставлення до стану здоров’я ваших улюбленців і зневажливе ставлення до правил гігієни ви можете заразитися різними хворобами.
Лептоспіроз
Це інфекційне захворювання, спричинене бактерією Leptospira. Найчастіше бактерія потрапляє у воду із сечею інфікованих гризунів, рідше інших тварин. Захворіти на лептоспіроз можна, контактуючи з інфікованими тваринами. У тіло людини бактерія лептоспірозу потрапляє через тріщини, порізи чи рани на шкірі чи слизових оболонках (очі, ніс, рот).
Лептоспіроз часто складно діагностувати, адже симптоми схожі на прояви інших захворювань – наприклад, можуть нагадувати грип, який більш характерний восени та взимку. До того ж, часом захворювання може протікати безсимптомно.
Воно може призвести до ураження нирок, печінки та менінгіту.
Детальніше тут: https://moz.gov.ua/article/health/scho-take-leptospiroz
Токсоплазмоз
Це інфекція, викликана Toxoplasma gondii. Вона поширена серед пташок та ссавців. Проте саме домашні кішки стають найкращим середовищем для існування цієї бактерії.
Заразитися нею можна через екскременти домашнього улюбленця. Наприклад, під час прибирання котячого туалету. Також токсоплазмозом можна захворіти при обробці сирого м’яса, або вживаючи погано проварене або просмажене м’ясо.
Часто хвороба протікає без симптомів, проте гостра форма може викликати нудоту, судоми, запалення лімфовузлів і високу температуру.
Захворювання особливо небезпечне для вагітних, адже може викликати серйозні патології у плода та навіть спровокувати викидень. Крім того, у немовляти може з’явитися вроджений токсоплазмоз, жовтяниця або розумова відсталість.
Сказ
Це вірусна, смертельна інфекція, розвиток якої у людини можна попередити введенням сироватки людям та вакцинацією тварин. Збудником є вірус Neuroryctes rabici.
Збудником є вірус Neuroryctes rabici.
Найчастіше спостерігається у диких тварин або підібраних з вулиці. Передається через кров, слизову та слину через укус. Запам’ятайте, що після укусу не треба чекати симптомів, краще одразу звернутися за медичною допомогою. Адже відразу виявити, що ви хворі, не вийде. Інкубаційний період становить від 10 днів.
Найкращий спосіб вберегтися від наслідків – це вакцинація. Всі, хто отримав травму, нанесену твариною з підозрою на сказ або ж підтвердженим сказом, мають обов’язково звернутися до лікарні та отримати безоплатну медичну допомогу.
Також ви можете зробити профілактичне щеплення. Із минулого року Україна почала закуповувати ці препарати на державному рівні. Детальніше про хворобу читайте тут: https://bit.ly/36i55dz
Сальмонельоз
Це гостре кишкове інфекційне захворювання, яке викликане бактеріями роду Salmonella. Симптомами хвороби можуть бути: пропасниця, діарея, порушення роботи шлунково-кишкового тракту. Можна підхопити під час контакту з тваринами або прибирання за ними. Сальмонели практично не реагують на антибіотики, тому лікування займає багато часу і зусиль.
Можна підхопити під час контакту з тваринами або прибирання за ними. Сальмонели практично не реагують на антибіотики, тому лікування займає багато часу і зусиль.
Про це читайте тут: https://bit.ly/343YIZG
Токсокароз
Це паразитарне захворювання, зумовлене нематодами, які паразитують у кишківнику собак (Toxocara canis) або кішок (Toxocara mystaх).
Найчастіше хвороба передається дітям через контакт із домашніми тваринами.
Симптомами токсокарозу є характерні висипання на тілі, опухає обличчя, лихоманка.Також збільшуються лімфатичні вузли. У частини хворих токсокароз викликає біль у животі, блювання, метеоризм, проноси. Часто виражені симптоми ураження центральної нервової системи. Якщо личинки потрапили в очі, то симптомами можуть бути почервоніння, зниження зору та білі вкраплення на зіницях..
Феліноз (у побуті — хвороба котячої подряпини).
Це гостре інфекційне захворювання, збудником якого є мікроорганізм групи ОЛТ Bartonella henselae. Резервуаром для інфекції є кішки (особливо сіамські), адже збудник хвороби є представником нормальної мікрофлори порожнини рота у котів.
Резервуаром для інфекції є кішки (особливо сіамські), адже збудник хвороби є представником нормальної мікрофлори порожнини рота у котів.
Симптоми хвороби: на місці укусу виникає утворення, ззовні схоже на укус комах, збільшення лімфовузлів, температура.
Рекомендації власникам тварин
- періодично проходьте профілактичні огляди;
- регулярно приводьте на профілактичні огляди до ветеринара свого улюбленця та вакцинуйте свою домашню тварину;
- після контакту з домашніми тваринами та після прибирання за ними ретельно мийте руки з милом під проточною водою;
- уникайте укусів і подряпин, якщо ж ви все-таки отримали пошкодження від тваринки, негайно продезінфікуйте рану;
- не дозволяйте вашим домашнім улюбленцям облизувати ваші порізи чи рани;
- не торкайтеся фекалій тварин та не прибирайте за твариною голіруч;
- не контактуйте з хворими тваринами.
Якщо вас вкусила або пошкрябала домашня тваринка без ознак хвороби, запам’ятайте:
- швидко та ретельно промийте уражене місце великою кількістю води з милом;
- дезінфікуйте рану за допомогою антисептичного засобу на основі спирту чи йоду.
 Не використовуйте перекис водню для дезінфекції.
Не використовуйте перекис водню для дезінфекції.
Якщо тварина виглядала не так як завжди, виявляла ознаки хвороби чи була хворою, після оброблення рани варто звернутися до лікаря.
За інформацією прес-служби МОЗ України
медицинская статья от специалистов центра реабилитации Благополучие
Энцефаломиелит — опасное поражение спинного и головного мозга, при котором иммунитет человека вырабатывает белки против собственной нервной ткани.
Симптомы энцефаломиелита
Существует несколько разновидностей энцефаломиелита в зависимости от того, какой именно участок мозга был поврежден. Поэтому симптомы также могут различаться, хотя эти различия больше видны при тяжелой форме заболевания. На начальном этапе различия минимальны. К признакам заболевания относят:
- усталость, вялое состояние, сонливость, недомогание без видимых причин, депрессия, которые могут сменяться приступами активности;
- головные и мышечные боли, регулярные боли в области позвоночника;
- повышенная температура тела при отсутствии простудных заболеваний;
- симптоматика простудного заболевания, например, заложенность носа, боль в горле;
- проблемы с пищеварением;
- нарушения речи;
- судороги, парезы или параличи, припадки, схожие по своей форме с эпилептическими, неврит лицевого нерва;
- появление на коже высыпаний, снижение чувствительности кожи;
- недержание мочи, сложности с мочеиспусканием или другая патология, связанная с функционированием органов малого таза;
- ухудшение зрение, пелена, черные точки перед глазами, пациент может испытывать регулярные боли в области глаз, особенно при движении;
- нарушения глотательной функции и функции дыхания.

Симптомы обычно появляются резко и являются ярко выраженными, сама болезнь развивается очень быстро.
Причины и факторы развития
Заболевание вызывает инфекция или интоксикация, но точные причины его развития полностью не изучены. Но существуют некоторые факторы риска, способные повлиять на состояние здоровья пациента и спровоцировать энцефаломиелит. К ним относят:
- Черепно-мозговые травмы, ушибы и сотрясения головного мозга.
- Вирусные инфекции, преимущественно характеризующиеся появлением на теле человека различных высыпаний (герпес, ветрянка, краснуха и др.).
- Бактериальные инфекции: токсоплазмоз, хламидиоз и др.
- Простудные заболевания, ОРВИ, грипп и др.
- Различные виды аллергии.
- Введение некоторых вакцин, в частности, против бешенства, кори, дифтерии и др.
- Сниженный иммунитет, регулярные стрессы, переутомление, травмы.
Считается, что вирус энцефаломиелита заразен, и здоровый человек может заболеть после тесного контакта с больным. Также вирус может проникнуть через желудочно-кишечный тракт или капельным путем. В группе риска находятся и пациенты с наследственной предрасположенностью.
Также вирус может проникнуть через желудочно-кишечный тракт или капельным путем. В группе риска находятся и пациенты с наследственной предрасположенностью.
Рассеянный энцефаломиелит
Рассеянный или острый энцефаломиелит по своей симптоматике похож на рассеянный склероз. Но если рассеянный склероз — хронический с периодами ремиссии, то энцефаломиелит является обратимым. Поэтому важно правильно поставить диагноз: только тогда можно подобрать эффективное лечение.
Эта форма энцефаломиелита характеризуется повышением температуры тела, болями в мышцах, речевыми нарушениями, ухудшением зрения, головными болями, головокружением и тошнотой. Пациенты сталкиваются с различными двигательными нарушениями: от тремора и гипертонуса до паралича, проблем с координацией и невозможностью ходить по заданной траектории. В особо тяжелых ситуациях пациент даже не может самостоятельно глотать еду.
Большинство изменений под действием терапии являются обратимыми и при грамотном лечении полностью исчезают.
Способы лечения рассеянного энцефаломиелита
К счастью для пациентов, энцефаломиелит поддается лечению и в ряде ситуаций исчезает полностью. Одни из главных условий: раннее начало терапии (буквально в первые дни после появления симптомов), точная диагностика (только точно определив пораженную область головного или спинного мозга можно подобрать корректную программу реабилитации) и стационарное лечение (любые попытки заняться самолечением могут лишь ухудшить ситуацию).
Программа лечения:
- Прием медикаментов. Пациентам назначают антибиотики, гормональные, жаропонижающие, антигистаминные, противовирусные и обезболивающие препараты, курс витаминов, анальгетики и др. Дозировку и график приема определяет врач. Ряд медикаментов направлен на коррекцию конкретных нарушений: восстановление функции дыхания, улучшение кровообращения головного мозга, нормализацию работы сердечно-сосудистой системы и др.
- Физиотерапия.
 Хорошие результаты дает массаж, лечебная физкультура, электростимуляция и другие процедуры, которые врач подбирает индивидуально.
Хорошие результаты дает массаж, лечебная физкультура, электростимуляция и другие процедуры, которые врач подбирает индивидуально. - Коррекция образа жизни. Не только во время лечения, но и в дальнейшей жизни пациент не должен употреблять алкоголь, также стоит избегать перегревов и переохлаждений, резкой смены температуры, переутомления.
Врачи центра «Благополучие» знают, что только при оперативном грамотном лечении пациенту можно вернуть здоровье, поэтому подбирают индивидуальную терапию с учетом и диагноза, и общего состояния пациента, и наличия сопутствующих заболеваний, и его возраста, а также других факторов. С больным работает целая бригада врачей. Мы наблюдаем за пациентами 24 часа в сутки, при двигательных нарушениях даем инвалидные кресла, обеспечиваем сиделками, готовыми оперативно отреагировать на любые изменения состояния больного. При этом мы стремимся создать комфортную позитивную атмосферу, чтобы все наши пациенты чувствовали себя уютно и спокойно, так как настрой играет большую роль в успехе реабилитации.
Мы добиваемся хороших результатов и стремимся вернуть абсолютное здоровье всем нашим пациентам. Вы можете обратиться к нам, если у вас рассеянный энцефаломиелит, диссеминированный миелит или другая форма заболевания.
Діагностика токсоплазмозу в Запоріжжі в МЦ «ШЕКИ»
Токсоплазмоз належить до паразитарних захворювань, які викликаються токсоплазмой — найпростішим паразитом. Заразитися ним можна, перш за все, від домашніх вихованців — кішок і собак. Паразитами багаті фекалії домашніх улюбленців, тому важливо дотримуватися правил гігієни при спілкуванні з ними, а також проводити періодично протипаразитарну терапію. Оскільки головна загроза цієї паразитарної інфекції — вагітні жінки, то при плануванні вагітності, необхідно здати аналізи на токсоплазмоз.
У Запоріжжі це можна зробити швидко і отримати 100% достовірний результат в медичному центрі «ШЕКИ». Аналіз проводиться декількома методиками — імуноферментним способом і ПЛР — дослідженням. Який саме аналіз необхідно здати пацієнтові, рекомендує лікар! Важливо, правильно підготуватися до здачі аналізу!
Який саме аналіз необхідно здати пацієнтові, рекомендує лікар! Важливо, правильно підготуватися до здачі аналізу!
Як можна заразитися токсоплазмозом?
Особлива загроза для інфікування — це кішки, інфіковані токсоплазмой. Однак, заразитися можна і через інші джерела:
Через вживання в їжу погано прожареного м’яса, особливо свинини, оленини і баранини, а також страв з яєць з недостатньою їх санітарною обробкою
- Через сире м’ясо і фарш
- Через погано вимиті руки при догляді за домашнім вихованцем і роботою в саду або на городі
- При трансплантології органів
- При вагітності від матері до дитини
Токсоплазмоз може протікати безсимптомно і ніяк не досажать людині, до моменту, коли його імунна система не дасть серйозний збій, наприклад, при таких захворюваннях, як рак, СНІД або інфекційні захворювання, серйозно знижують можливість організму боротися з паразитом. Тоді він починає розмножуватися і вражати тканини органів, систем, в тому числі і нервову систему, викликаючи набряк мозку і інші, несумісні з життям патології.
Тоді він починає розмножуватися і вражати тканини органів, систем, в тому числі і нервову систему, викликаючи набряк мозку і інші, несумісні з життям патології.
Токсоплазмоз при вагітності
Головним ударом при токсоплазмозі є вагітні жінки, так як зараження їм в період вагітності викликає загибель плода, патології розвитку, несумісні з життям. Якщо вагітна жінка нагородить немовляти токсоплазмою, то ймовірність його виживання — мінімальна! Тому, при вагітності, важливо, щоб жінка не брала на себе догляд за домашнім вихованцем, особливо прибирання його туалету. Також ретельно слід стежити за дотриманням гігієнічних правил, а також не вживати м’ясні продукти в місцях сумнівної репутації і спонтанної торгівлі. Не варто спокушатися на шашлики в придорожньому кафе або чебуреки! При роботі в саду або на дачі обов’язково потрібно надягати рукавички і ретельно мити руки і овочі, з грядок. Адже, навіть, якщо у вас немає в будинку кішки, на сусідніх дачах або ділянках вони можуть проживати, а відомо, що кішки «гуляють, де заманеться», тому їх фекалії можуть бути і на ваших грядках.
Форми токсоплазмозу
Розрізняють:
- Гостру форму. При ній пацієнт відчуває високий жар, болі в м’язах, лімфоденопатія, запалення в суглобах, на тілі з’являється макулопапульозний висип. Можуть бути збільшені печінка і селезінка. Гостра форма досить небезпечна, оскільки може викликати серйозні зміни в органах, в тому числі і в нервовій системі (енцефаліт, менінгоенцефаліт)
- Хронічну. При хронічному перебіг хвороби, пацієнт відчуває періодичні нездужання, пов’язані з інтоксикацією організму, порушенням роботи всіх органів і систем організму
- Латентну форму. Протікає безсимптомно і визначається тільки шляхом серологічних досліджень.
Дуже небезпечні будь-які форми перебігу хвороби для людей з імунодефіцитом.
Виявити небезпечного паразита в організмі допоможуть лабораторні дослідження. Здати аналізи імуноферментним способом (ІФА) і ПЛР, можна в медичному центрі «ШЕКИ» в Запоріжжі.
«Вроджена пневмонія у немовлят залежить від здоров’я матері». Кропивницька лікарка
Вроджена пневмонія у немовлят залежить від здоров’я матері. Тому, перш ніж планувати вагітність, кожна жінка має пройти медичне обстеження, розповіла лікарка-пульманолог дитячої обласної лікарні Надія Дегтяр. До Всесвітнього дня боротьби з пневмонією, який відзначають 12 листопада, Суспільне розповість про причини та профілактику цієї недуги у дітей.
Причини захворювання
Вроджена пневмонія – це гостре інфекційне запальне захворювання респіраторних відділів легень та бронхів. Ця хвороба характерна для новонароджених дітей. У немовлят недуга розвивається протягом 72 годин після народження. Щоб підтвердити вроджену пневмонію, дитині роблять рентген, сказал Надія Дегтяр.
Пневмонія може розвиватися внутрішньоутробно, тобто йде зараження від матері, при проходженні дитини родовими шляхами і при контакті з хворими людьми.
«Вроджена пневмонія, практично, на 80% залежить від здоров’я матері. Тому жінка, перш ніж вагітніти, має пройти обстеження на торч-інфекції: токсоплазмоз, краснуха, цитомегаловірус і герпес. Це ті інфекції, які передаються трансплацентарно від матері дитині».
Крім здоров’я матері, вроджена пневмонія залежить від патології бронхів та серцево-судинної системи. Недуга може з’являтися у недоношених дітей, які народжуються з вагою від 700 грамів. Це захворювання розвивається дуже швидко, тому що у них нерозправлені легені.
Надія Дегтяр пояснила: крім жінки, медичне обстеження має пройти і майбутній батько. «Наприклад, заразитись токсоплазмозом можна у побуті. Багато з нас тримають вдома папуг, котів, які є переносниками цього захворювання. У сільській місцевості – це кури, качки. Токсоплазмоз може клінічно не проявлятися у матері».
Бактеріальна та вірусні пневмонії
Крім вродженої, діти хворіють на вірусні і бактеріальні пневмонії. Надія Дегтяр розповіла, як розпізнати захворювання.
«Зазвичай вірусна інфекція тримається п’ять-сім днів і минає, залишається невеликий кашель та нежить. Якщо у дитини продовжує триматися висока температура, якщо вона в’яла, бліда, не хоче їсти, більше спить, тоді можна припускати, що це вже йде розвиток пневмонії. Треба негайно звертатися до лікаря».
Відрізнити бактеріальну та вірусну пневмонії можна з допомогою рентгену.
Профілактика пневмоній
За словами Надії Дегтяр, є специфічна та неспецифічна профілактика пневмонії. Неспецифічна – це належний рівень життя дитини, збалансоване харчування та щоденне перебування на свіжому повітрі.
Специфічна – вакцинація від пневмоній. Лікарка рекомендує робити відповідні щеплення дітям, які з раннього віку ходять в дитсадок, ослаблені, недоношені або часто хворіють застудними захворюваннями, пневмоніями, отитами або бронхітами.
«У календар планових щеплень входить безкоштовна вакцинація новонароджених. Залежно від віку, перше щеплення дозволяють робити з шести тижнів до шести місяців, вона захищає дітей до п’яти років. І є вакцина, яка не входить до календаря щеплень. Вона є платною та захищає від 13 видів пневмококової інфекції».
І є вакцина, яка не входить до календаря щеплень. Вона є платною та захищає від 13 видів пневмококової інфекції».
Хворих на пневмонію дітей лікують у педіатричному відділенні №2 дитячої обласної лікарні. У зв’язку з реформою, в лікарні об’єднали пульмонологічне, алергологічне та ревматологічне відділення.
З початку 2021 року пролікували 125 дітей віком до 18 років. За словами Надії Дегтяр, у 2020 та за дев’ять місяців 2021 року ніхто від цього захворювання не помер.
Що відомоВсесвітній день боротьби з пневмонією відзначають 12 листопада. Дату обрали з ініціативи Глобальної коаліції проти дитячої пневмонії. Мета – підвищення обізнаності населення про пневмонії і сприяння заходам з профілактики та лікування цього захворювання.
Читайте такожТоксоплазмоз | Американская ветеринарная медицинская ассоциация
Токсоплазмоз — это заболевание, вызываемое микроскопическим простейшим паразитом, называемым Toxoplasma gondii (T. gondii) . Многие теплокровные животные, включая большинство домашних животных, домашний скот, птиц и людей, могут заразиться T. gondii .
gondii) . Многие теплокровные животные, включая большинство домашних животных, домашний скот, птиц и людей, могут заразиться T. gondii .
В то время как почти все теплокровные животные могут содержать в своем мясе паразита Toxoplasma , кошки (все виды кошек, а не только домашние кошки) являются окончательным хозяином для T.гондии . Это означает, что они являются единственными животными, которые выделяют ооцисты, устойчивую к окружающей среде стадию паразита, в своем стуле, чтобы заразить другие виды животных (включая людей).
Токсоплазма у кошекКошки являются окончательными хозяевами T. gondii . Кошки чаще всего заражаются T. gondii , когда они охотятся на инфицированных мышей, птиц и других мелких животных. Для кошек, живущих только в помещении, наиболее вероятным источником инфекции являются остатки сырого мяса или сырое мясо.
У инфицированных животных в тканях развиваются кисты, содержащие паразита. Когда кошка съедает мясо или другие ткани инфицированных животных и заражается T. gondii , паразит может жить в тканях кошки всю жизнь кошки. Почти треть кошек в США имеют в крови антитела к T. gondii . При первоначальном заражении T. gondii кошка может выделять миллионы ооцист со стулом каждый день в течение нескольких дней. Люди или другие животные, подвергшиеся воздействию инфекционных ооцист, затем заражаются вирусом T.gondii паразит. После начального периода линьки у большинства кошек ооцисты не выделяются с фекалиями. Кошки, выделяющие ооцисты, обычно не выглядят больными, и ооцисты не видны невооруженным глазом.
Когда кошка съедает мясо или другие ткани инфицированных животных и заражается T. gondii , паразит может жить в тканях кошки всю жизнь кошки. Почти треть кошек в США имеют в крови антитела к T. gondii . При первоначальном заражении T. gondii кошка может выделять миллионы ооцист со стулом каждый день в течение нескольких дней. Люди или другие животные, подвергшиеся воздействию инфекционных ооцист, затем заражаются вирусом T.gondii паразит. После начального периода линьки у большинства кошек ооцисты не выделяются с фекалиями. Кошки, выделяющие ооцисты, обычно не выглядят больными, и ооцисты не видны невооруженным глазом.
Большинство инфицированных взрослых кошек выглядят здоровыми. Однако у некоторых кошек может развиться пневмония, повреждение печени и другие проблемы со здоровьем. Признаки болезни у кошек включают вялость, потерю аппетита, кашель, затрудненное дыхание, диарею, желтуху, слепоту, изменения личности, проблемы со зрением и другие неврологические проблемы. Причина, по которой одни кошки заболевают, а другие нет, неизвестна, но котята и кошки с ослабленным иммунитетом (например, те, которые также инфицированы вирусом кошачьей лейкемии и/или вирусом кошачьего иммунодефицита [FIV]), по-видимому, имеют повышенный риск заболевания. В настоящее время вакцины против T. gondii не существует, но лечение может быть эффективным, если заболевание диагностировано на ранней стадии. Анализ крови на антитела T. gondii может помочь в диагностике токсоплазмоза у больных кошек.
Причина, по которой одни кошки заболевают, а другие нет, неизвестна, но котята и кошки с ослабленным иммунитетом (например, те, которые также инфицированы вирусом кошачьей лейкемии и/или вирусом кошачьего иммунодефицита [FIV]), по-видимому, имеют повышенный риск заболевания. В настоящее время вакцины против T. gondii не существует, но лечение может быть эффективным, если заболевание диагностировано на ранней стадии. Анализ крови на антитела T. gondii может помочь в диагностике токсоплазмоза у больных кошек.
Несмотря на то, что заражение паразитом относительно часто встречается у людей, фактическое заболевание встречается редко.По оценкам Центров США по контролю и профилактике заболеваний (CDC), почти четверть населения США в возрасте 12 лет и старше инфицированы T. gondii ; к счастью, здоровая иммунная система обычно держит паразита под контролем и предотвращает болезнь. Признаки заболевания включают легкие гриппоподобные симптомы, такие как лихорадка, легкие боли и увеличение лимфатических узлов в течение короткого периода времени, и лечение антибиотиками, как правило, не требуется. У людей с ослабленным иммунитетом (т.г., ВИЧ/СПИД-положительные, лица, получающие противораковую химиотерапию и др.) паразит вызывает более тяжелое заболевание, требующее лечения антибиотиками. Инфекция T. gondii была предложена в качестве фактора риска тяжелых психических заболеваний у людей, но причинно-следственная связь не установлена.
У людей с ослабленным иммунитетом (т.г., ВИЧ/СПИД-положительные, лица, получающие противораковую химиотерапию и др.) паразит вызывает более тяжелое заболевание, требующее лечения антибиотиками. Инфекция T. gondii была предложена в качестве фактора риска тяжелых психических заболеваний у людей, но причинно-следственная связь не установлена.
Люди могут заразиться Toxoplasma gondii несколькими путями:
- Обработка или употребление в пищу недоваренного или сырого мяса, особенно свинины, является наиболее распространенным путем заражения в Северной Америке. Тканевые цисты T. gondii могут быть обнаружены в мясе овец, свиней, коз и дичи. Реже встречаются у птицы и крупного рогатого скота. Вяленое, сушеное или копченое мясо местного производства также может представлять повышенный риск заражения.
- Употребление сырого, непастеризованного молока (включая козье молоко) и молочных продуктов.
- Обработка или употребление в пищу немытых фруктов или овощей, которые могли быть загрязнены почвой, содержащей инфекционные ооцисты.

- Употребление сырых устриц, моллюсков или мидий.Ооцисты T. gondii могут месяцами выживать в морской воде.
- Проглатывание инфекционных ооцист из окружающей среды. Такие виды деятельности, как садоводство, повышают риск заражения из-за прямого контакта с почвой или водой, которые могут быть заражены кошачьими фекалиями и инфекционными ооцистами. Поскольку бездомные или одичавшие кошки могут рассматривать детскую песочницу как лоток, песочницы на открытом воздухе представляют риск заражения детей T. gondii .
- Передача непосредственно нерожденному ребенку от матери, когда она заражается T.gondii во время беременности.
Toxoplasma gondii Ооцисты должны находиться в окружающей среде не менее 24 часов (до 5 дней, в зависимости от условий внешней среды), чтобы стать заразными для других животных, включая людей. Они с большей вероятностью выживут в теплой и влажной среде. Ооцисты очень устойчивы и могут жить в окружающей среде месяцами и даже годами.
Маловероятно, что контакт с кошками может представлять риск заражения.
Было высказано предположение, что контакт с кошками представляет риск заражения, но маловероятно, что это действие связано с риском заражения T.gondii для человека. Поскольку большинство здоровых кошек часто ухаживают за собой, и требуется минимум 24 часа, прежде чем ооцисты в фекалиях станут заразными, маловероятно, что фекалии останутся на их шерсти достаточно долго, чтобы какие-либо ооцисты стали заразными.
Беременные женщины и люди с ослабленным иммунитетом подвергаются более высокому риску заражения токсоплазмозом. Обычно люди, у которых развился токсоплазмоз после заражения вирусом иммунодефицита человека (ВИЧ), подвергались воздействию паразита T. gondii в более раннем возрасте, и иммуносупрессия, вызванная ВИЧ-инфекцией, позволяла паразиту реактивироваться и расти беспрепятственно.Токсоплазмоз у этих пациентов может привести к тяжелым неврологическим заболеваниям, судорогам, параличу, коме и смерти, несмотря на соответствующее лечение.
Женщины, подвергшиеся воздействию T. gondii во время беременности, могут передать инфекцию плоду, что приведет к врожденной инфекции у младенца. Если мать инфицирована T. gondii в течение первого триместра, инфекция может вызвать тяжелое заболевание, приводящее к гибели плода, заболеваниям глаз или нервной системы. Инфекции, приобретенные на более поздних сроках беременности, менее опасны.Хотя у большинства инфицированных младенцев при рождении симптомы не проявляются, у многих из них, вероятно, появятся признаки инфекции в более позднем возрасте. Дети, врожденно инфицированные T. gondii , могут страдать от потери зрения, умственного развития, потери слуха и, в тяжелых случаях, смерти. Женщины могут быть проверены на антитела T. gondii в крови, которые указывают на инфекцию. Женщины, инфицированные до беременности, будут защищены от паразита и не рискуют передать инфекцию своему будущему ребенку.
Тем не менее, люди с ослабленным иммунитетом и беременные люди, безусловно, могут иметь домашних животных в своей жизни и получать пользу от общения с животными. Владельцы кошек с ослабленным иммунитетом или беременные не должны чувствовать себя обязанными отказаться от своих питомцев. Меры здравого смысла, которые могут предотвратить инфекцию, перечислены ниже. Если вы беременны или имеете ослабленный иммунитет, обсудите свои опасения со своим врачом и ветеринаром.
Владельцы кошек с ослабленным иммунитетом или беременные не должны чувствовать себя обязанными отказаться от своих питомцев. Меры здравого смысла, которые могут предотвратить инфекцию, перечислены ниже. Если вы беременны или имеете ослабленный иммунитет, обсудите свои опасения со своим врачом и ветеринаром.
Как можно предотвратить контакт с
T. gondii ?Общие меры предосторожности:
- Мойте руки водой с мылом сразу после работы с землей или после контакта с сырым или недоваренным мясом, овощами или непастеризованными молочными продуктами.
- Избегайте употребления сырого молока или других непастеризованных молочных продуктов.
- Тщательно мойте фрукты и овощи перед едой, особенно выращенные на заднем дворе.
- Кипятите воду из прудов и ручьев во время кемпинга/похода.
- Во время приготовления старайтесь не пробовать мясо, пока оно не будет полностью приготовлено.
- Готовьте мясо при соответствующей температуре, чтобы уничтожить ооцисты.
 Информацию о подходящей температуре можно найти на сайте www.cdc.gov/toxoplasmosis/prevent.
Информацию о подходящей температуре можно найти на сайте www.cdc.gov/toxoplasmosis/prevent. - Тщательно мойте и дезинфицируйте разделочные доски, ножи, раковины и столы сразу после разделки мяса.
- Накрывайте все ящики с песком снаружи, когда они не используются, чтобы кошки не использовали их как лотки.
Для владельцев кошек:
- Помните, что у вас больше шансов заразиться T. gondii от недоваренного мяса или окружающей среды, чем от вашей кошки, и примите меры предосторожности, перечисленные выше, чтобы защитить себя.
- Держите кошку в помещении — не позволяйте кошке(ам) охотиться на грызунов и птиц.
- Избегайте сырых продуктов.Кормите кошек только приготовленным мясом или полуфабрикатами.
- Ежедневно меняйте кошачий туалет до того, как ооцисты T. gondii «созреют» и станут заразными.
- Безопасно утилизируйте использованный наполнитель, предпочтительно в герметичном пластиковом пакете.

- Если у вашей кошки длинная шерсть на задней части, которая имеет тенденцию собирать фекалии, аккуратно подстригите шерсть или отдайте кошку на профессиональный уход, чтобы поддерживать чистоту в этой области. Точно так же, если у вашей кошки слишком избыточный вес, она больна или страдает артритом, чтобы надлежащим образом ухаживать за собой, вам, возможно, придется ухаживать за кошкой (после этого вымыть руки) или поручить ей профессиональную стрижку.
Если вы беременны или у вас ослаблен иммунитет, соблюдайте следующие дополнительные меры предосторожности:
- По возможности не прикасайтесь к бездомным кошкам и не берите новых кошек во время беременности или болезни. Если в это время в вашей семье появится новая кошка, немедленно отправьте ее на тщательное обследование к ветеринару, чтобы убедиться, что она здорова, и ответить на любые вопросы, которые могут у вас возникнуть.
- Примите дополнительные меры предосторожности (мытье рук и т.
 д.), чтобы избежать контакта с кошачьими фекалиями.
д.), чтобы избежать контакта с кошачьими фекалиями. - Если у вас есть кошка, по возможности не меняйте лоток (например, попросите супруга, соседа по комнате и т. д. сменить лоток) или меняйте его ежедневно (во избежание контакта с ооцистами после того, как у них было достаточно времени, чтобы стать заразными). ), используйте при этом резиновые перчатки, а затем тщательно вымойте руки.
Для получения дополнительной информации о токсоплазмозе у людей посетите веб-сайт www.cdc.gov/parasites/toxoplasmosis.
Содержимое этой страницы представляет собой сжатую версию нашей брошюры Toxoplasmosis, доступной на английском и испанском .
CDC – Токсоплазмоз – Биология
Возбудитель:
Toxoplasma gondii — простейший паразит, поражающий большинство видов теплокровных животных, включая человека, и вызывающий заболевание токсоплазмоз.
Жизненный цикл:
Единственными известными окончательными хозяевами Toxoplasma gondii являются представители семейства кошачьих (домашние кошки и их родственники). Неспорулированные ооцисты выделяются с фекалиями кошек. Хотя ооцисты обычно выделяются только в течение 1–3 недель, может выделяться большое количество.Ооцистам требуется 1–5 дней, чтобы спорулировать в окружающей среде и стать инфекционными. Промежуточные хозяева в природе (включая птиц и грызунов) заражаются при проглатывании почвы, воды или растительного материала, зараженного ооцистами. Ооцисты превращаются в тахизоиты вскоре после проглатывания. Эти тахизоиты локализуются в нервной и мышечной ткани и развиваются в тканевые кистозные брадизоиты. Кошки заражаются после употребления в пищу промежуточных хозяев, несущих тканевые цисты. Кошки также могут заразиться непосредственно при проглатывании спорулированных ооцист.Животные, разводимые для употребления в пищу человеком, и дичь также могут заразиться тканевыми кистами после проглатывания спорулированных ооцист из окружающей среды. Люди могут заразиться любым из нескольких путей:
Неспорулированные ооцисты выделяются с фекалиями кошек. Хотя ооцисты обычно выделяются только в течение 1–3 недель, может выделяться большое количество.Ооцистам требуется 1–5 дней, чтобы спорулировать в окружающей среде и стать инфекционными. Промежуточные хозяева в природе (включая птиц и грызунов) заражаются при проглатывании почвы, воды или растительного материала, зараженного ооцистами. Ооцисты превращаются в тахизоиты вскоре после проглатывания. Эти тахизоиты локализуются в нервной и мышечной ткани и развиваются в тканевые кистозные брадизоиты. Кошки заражаются после употребления в пищу промежуточных хозяев, несущих тканевые цисты. Кошки также могут заразиться непосредственно при проглатывании спорулированных ооцист.Животные, разводимые для употребления в пищу человеком, и дичь также могут заразиться тканевыми кистами после проглатывания спорулированных ооцист из окружающей среды. Люди могут заразиться любым из нескольких путей:- Употребление в пищу недоваренного мяса животных с тканевыми кистами.

- Потребление пищи или воды, загрязненных кошачьими фекалиями или загрязненными образцами окружающей среды (например, загрязненной фекалиями почвой или изменением туалетного лотка домашней кошки).
- Переливание крови или трансплантация органов.
- Трансплацентарно от матери к плоду.
У человека-хозяина паразиты образуют тканевые кисты, чаще всего в скелетных мышцах, миокарде, головном мозге и глазах; эти кисты могут оставаться на протяжении всей жизни хозяина. Диагноз обычно устанавливается с помощью серологии, хотя в окрашенных образцах биопсии могут наблюдаться тканевые кисты. Диагноз врожденных инфекций может быть достигнут путем обнаружения ДНК T. gondii в амниотической жидкости с использованием молекулярных методов, таких как ПЦР.
Изображение жизненного цикла и информация предоставлены DPDx.
Toxoplasma gondii и глазной токсоплазмоз: патогенез.
Br J Офтальмол. 1996 декабрь; 80 (12): 1099–1107.
Глазная больница Мурфилдс, Лондон.
Эта статья была процитирована другими статьями в PMC.Полный текст
Полный текст доступен в виде отсканированной копии оригинальной печатной версии. Получите копию для печати (файл PDF) полной статьи (5.0M) или щелкните изображение страницы ниже, чтобы просмотреть страницу за страницей.Ссылки на PubMed также доступны для Selected References .
Изображения в этой статье
Нажмите на изображение, чтобы увеличить его.
Избранные ссылки
Эти ссылки находятся в PubMed. Возможно, это не полный список литературы из этой статьи.
- Stone WB, Manwell RD. Токсоплазмоз у хладнокровных хозяев. J Протозол. 1969, февраль; 16 (1): 99–102. [PubMed] [Google Scholar]
- Кин Б.Х. Клинический токсоплазмоз — 50 лет.Trans R Soc Trop Med Hyg. 1972; 66 (4): 549–571. [PubMed] [Google Scholar]
- WOODS AC, JACOBS L, WOOD RM, COOK MK. Изучение роли токсоплазмоза в развитии хориоретинита у взрослых.
 Am J Офтальмол. 1954 г., февраль; 37 (2): 163–177. [PubMed] [Google Scholar]
Am J Офтальмол. 1954 г., февраль; 37 (2): 163–177. [PubMed] [Google Scholar] - Newman PE, Ghosheh R, Tabbara KF, O’Connor GR, Stern W. Роль реакций гиперчувствительности на антигены токсоплазмы при экспериментальном токсоплазмозе глаз у нечеловеческих приматов. Am J Офтальмол. 1982 г., август; 94 (2): 159–164. [PubMed] [Google Scholar]
- Dubey JP, Miller NL, Frenkel JK.Характеристика новой фекальной формы Toxoplasma gondii. J Паразитол. 1970 г., июнь; 56 (3): 447–456. [PubMed] [Google Scholar]
- Miller NL, Frenkel JK, Dubey JP. Оральные инфекции цистами и ооцистами токсоплазмы у кошек, других млекопитающих и птиц. J Паразитол. 1972 г., октябрь; 58 (5): 928–937. [PubMed] [Google Scholar]
- Тесслер Х.Х. Глазной токсоплазмоз. Международная офтальмологическая клиника. Осень 1981 г .; 21 (3): 185–199. [PubMed] [Google Scholar]
- Dubey JP. Влияние замораживания на заразность цист токсоплазмы для кошек.J Am Vet Med Assoc. 1974 г., 15 сентября; 165 (6): 534–536.
 [PubMed] [Google Scholar]
[PubMed] [Google Scholar] - Френкель Дж. К., Руис А., Шиншилла М. Выживание ооцист токсоплазмы в почве в Канзасе и Коста-Рике. Am J Trop Med Hyg. 1975 г., май; 24 (3): 439–443. [PubMed] [Google Scholar]
- Coutinho SG, Lobo R, Dutra G. Выделение токсоплазмы из почвы во время вспышки токсоплазмоза в сельской местности в Бразилии. J Паразитол. 1982 г., октябрь; 68 (5): 866–868. [PubMed] [Google Scholar]
- Dubey JP, Miller NL, Frenkel JK.Ооциста Toxoplasma gondii из кошачьих фекалий. J Эксперт Мед. 1970 г., 1 октября; 132 (4): 636–662. [Бесплатная статья PMC] [PubMed] [Google Scholar]
- Sheffield HG, Melton ML. Тонкая структура и размножение Toxoplasma gondii. J Паразитол. 1968 г., апрель; 54 (2): 209–226. [PubMed] [Google Scholar]
- Гросс Р., Гроссер К.Д., Бирштедт П., Дек К., Герхард В., Хабихт В., Штайнбрюк Г. Медицинское отделение интенсивной терапии в большом городе. Ger Med Mon. 1969 г., январь; 14 (1): 1–7. [PubMed] [Google Scholar]
- LUND E, LYCKE E, SOURANDER P.
 Кинематографическое исследование Toxoplasma gondii в культурах клеток. Br J Exp патол. 1961, август; 42: 357–362. [Бесплатная статья PMC] [PubMed] [Google Scholar]
Кинематографическое исследование Toxoplasma gondii в культурах клеток. Br J Exp патол. 1961, август; 42: 357–362. [Бесплатная статья PMC] [PubMed] [Google Scholar] - Zaman V, Colley FC. Ультраструктурное исследование проникновения Toxoplasma gondii в макрофаги. Trans R Soc Trop Med Hyg. 1972; 66 (5): 781–782. [PubMed] [Google Scholar]
- Jones TC, Yeh S, Hirsch JG. Взаимодействие между Toxoplasma gondii и клетками млекопитающих. I. Механизм проникновения и внутриклеточная судьба паразита. J Эксперт Мед.1972 г., 1 ноября; 136 (5): 1157–1172. [Бесплатная статья PMC] [PubMed] [Google Scholar]
- Olliaro P, Marchetti A, Regazzetti A, Fabbi M, Gorini G. Вирулентность Toxoplasma gondii: изменение модели при различных условиях содержания. Параситология. 1993 г., декабрь; 35 (1–3): 17–19. [PubMed] [Google Scholar]
- Лекомт В., Чумпитази Б. Ф., Паскье Б., Амбруаз-Томас П., Санторо Ф. Кисты мозговой ткани у крыс, инфицированных штаммом резус-фактора Toxoplasma gondii.
 Паразитол рез. 1992;78(3):267–269. [PubMed] [Google Scholar]
Паразитол рез. 1992;78(3):267–269. [PubMed] [Google Scholar] - Guo ZG, Johnson AM.Генетическая характеристика штаммов Toxoplasma gondii методом случайной амплификации полиморфной ДНК-полимеразной цепной реакции. Паразитология. 1995 г., август; 111 (часть 2): 127–132. [PubMed] [Google Scholar]
- Rinder H, Thomschke A, Dardé ML, Löscher T. Специфические полиморфизмы ДНК различают вирулентность и невирулентность для мышей девяти штаммов Toxoplasma gondii. Мол Биохим Паразитол. 1995 г., январь; 69 (1): 123–126. [PubMed] [Google Scholar]
- Декерт-Шлютер М., Шлютер Д., Шмидт Д., Швендеманн Г., Вистлер О.Д., Хоф Х.Токсоплазменный энцефалит у конгенных мышей B10 и BALB: влияние генетических факторов на иммунный ответ. Заразить иммун. 1994 г., январь; 62 (1): 221–228. [Бесплатная статья PMC] [PubMed] [Google Scholar]
- Chiappino ML, Nichols BA, O’Connor GR. Сканирующая электронная микроскопия Toxoplasma gondii: перекручивание паразита и реакция клетки-хозяина во время инвазии.
 J Протозол. 1984 г., май; 31 (2): 288–292. [PubMed] [Google Scholar]
J Протозол. 1984 г., май; 31 (2): 288–292. [PubMed] [Google Scholar] - Николс Б.А., Чиаппино М.Л. Цитоскелет Toxoplasma gondii. J Протозол. 1987 г., май; 34 (2): 217–226.[PubMed] [Google Scholar]
- Bommer W, Heunert HH, Milthaler B. Kinematographische Studien über die Eigenbewegung von Toxoplasma gondii. З Тропенмед Паразитол. 1969 г., декабрь; 20 (4): 450–458. [PubMed] [Google Scholar]
- Николс Б.А., О’Коннор Г.Р. Проникновение простейших Toxoplasma gondii в перитонеальные макрофаги мыши. Новые доказательства активной инвазии и фагоцитоза. Лаборатория Инвест. 1981 г., апрель; 44 (4): 324–335. [PubMed] [Google Scholar]
- Николс Б.А., Чиаппино М.Л., О’Коннор Г.Р.Секреция ротрий Toxoplasma gondii во время инвазии клеток-хозяев. J Ultrastruct Res. 1983 г., апрель; 83 (1): 85–98. [PubMed] [Google Scholar]
- Норрби Р. Иммунологическое исследование фактора проникновения токсоплазмы в клетку-хозяина. Заразить иммун. 1971 г., февраль; 3 (2): 278–286.
 [Бесплатная статья PMC] [PubMed] [Google Scholar]
[Бесплатная статья PMC] [PubMed] [Google Scholar] - Lycke E, Carlberg K, Norrby R. Взаимодействие между Toxoplasma gondii и ее клетками-хозяевами: функция фактора, усиливающего проникновение токсоплазмы. Заразить иммун.1975 г., апрель; 11 (4): 853–861. [Бесплатная статья PMC] [PubMed] [Google Scholar]
- Kimata I, Tanabe K. Секреция Toxoplasma gondii антигена, который, по-видимому, связывается с мембраной паразитофорной вакуоли при инвазии клетки-хозяина. Дж. Клеточные науки. 1987 г., сентябрь 88 (часть 2): 231–239. [PubMed] [Google Scholar]
- Садак А., Таги З., Фортиер Б., Дубремец Дж. Ф. Характеристика семейства белков роптри Toxoplasma gondii. Мол Биохим Паразитол. 1988 июнь; 29 (2-3): 203–211. [PubMed] [Google Scholar]
- Шварцман Д.Д.Ингибирование фактора усиления проникновения Toxoplasma gondii моноклональными антителами, специфичными к роптриям. Заразить иммун. 1986 г., март; 51 (3): 760–764. [Бесплатная статья PMC] [PubMed] [Google Scholar]
- Sibley LD, Krahenbuhl JL, Adams GM, Weidner E.
 Toxoplasma модифицирует фагосомы макрофагов путем секреции везикулярной сети, богатой поверхностными белками. Джей Селл Биол. 1986 г., сен; 103 (3): 867–874. [Бесплатная статья PMC] [PubMed] [Google Scholar]
Toxoplasma модифицирует фагосомы макрофагов путем секреции везикулярной сети, богатой поверхностными белками. Джей Селл Биол. 1986 г., сен; 103 (3): 867–874. [Бесплатная статья PMC] [PubMed] [Google Scholar] - Wilson CB, Tsai V, Remington JS. Неспособность вызвать окислительный метаболический взрыв нормальными макрофагами: возможный механизм выживания внутриклеточных патогенов.J Эксперт Мед. 1980 г., 1 февраля; 151 (2): 328–346. [Бесплатная статья PMC] [PubMed] [Google Scholar]
- JACOBS L, REMINGTON JS, MELTON ML. Исследование образцов мяса свиней, крупного рогатого скота и овец на наличие инцистированной токсоплазмы. J Паразитол. 1960, февраль; 46: 23–28. [PubMed] [Google Scholar]
- Catár G, Bergendi L, Holkovă R. Выделение Toxoplasma gondii от свиней и крупного рогатого скота. J Паразитол. 1969, октябрь; 55 (5): 952–955. [PubMed] [Google Scholar]
- JACOBS L, REMINGTON JS, MELTON ML. Резистентность инцистированной формы Toxoplasma gondii.J Паразитол.
 1960, февраль; 46: 11–21. [PubMed] [Google Scholar]
1960, февраль; 46: 11–21. [PubMed] [Google Scholar] - Krug EC, Marr JJ, Berens RL. Метаболизм пуринов у Toxoplasma gondii. Дж. Биол. Хим. 1989 г., 25 июня; 264 (18): 10601–10607. [PubMed] [Google Scholar]
- Remington JS, Gentry LO. Приобретенный токсоплазмоз: инфекция против болезней. Энн Н.Ю. Академия наук. 1970 г., 30 октября; 174 (2): 1006–1017. [PubMed] [Google Scholar]
- Siegel SE, Lunde MN, Gelderman AH, Halterman RH, Brown JA, Levine AS, Graw RG., Jr Передача токсоплазмоза при переливании лейкоцитов.Кровь. 1971 г., апрель; 37 (4): 388–394. [PubMed] [Google Scholar]
- Pauleikhoff D, Messmer E, Beelen DW, Foerster M, Wessing A. Трансплантация костного мозга и токсоплазматический ретинохориоидит. Graefes Arch Clin Exp Офтальмол. 1987;225(3):239–243. [PubMed] [Google Scholar]
- Саари М., Райсанен С. Передача острой токсоплазменной инфекции. Выживаемость трофозоитов в слезах, слюне, моче человека и в коровьем молоке. Acta Ophthalmol (Копенг) 1974;52(6):847–852.
 [PubMed] [Google Scholar]
[PubMed] [Google Scholar] - Скорич Д.Н., Чиаппино М.Л., Николс Б.А.Поражение конъюнктивы морской свинки Toxoplasma gondii. Invest Ophthalmol Vis Sci. 1988 декабрь; 29 (12): 1871–1880. [PubMed] [Google Scholar]
- Sabin AB, Feldman HA. Красители как микрохимические индикаторы нового иммунного феномена при воздействии простейшего паразита (токсоплазмы). Наука. 1948 г., 10 декабря; 108 (2815): 660–663. [PubMed] [Google Scholar]
- Desmonts G, Couvreur J. Токсоплазмоз во время беременности и его передача плоду. Бюлл. Н.Ю. акад. мед. 1974 г., февраль; 50 (2): 146–159. [Бесплатная статья PMC] [PubMed] [Google Scholar]
- Alford CA, Jr, Stagno S, Reynolds DW.Врожденный токсоплазмоз: клинические, лабораторные и терапевтические соображения с особым упором на субклиническое течение заболевания. Бюлл. Н.Ю. акад. мед. 1974 г., февраль; 50 (2): 160–181. [Бесплатная статья PMC] [PubMed] [Google Scholar]
- Harris ED, Jr, McCroskery PA. Влияние температуры и стабильности фибрилл на деградацию хрящевого коллагена ревматоидной синовиальной коллагеназой.
 N Engl J Med. 1974 г., 3 января; 290 (1): 1–6. [PubMed] [Google Scholar]
N Engl J Med. 1974 г., 3 января; 290 (1): 1–6. [PubMed] [Google Scholar] - Wilson CB, Remington JS, Stagno S, Reynolds DW.Развитие неблагоприятных последствий у детей, рожденных с субклинической врожденной токсоплазменной инфекцией. Педиатрия. 1980 ноябрь; 66 (5): 767–774. [PubMed] [Google Scholar]
- БЕВЕРЛИ Дж. К. Врожденная передача токсоплазмоза через последующие поколения мышей. Природа. 1959 г., 9 мая; 183 (4671): 1348–1349. [PubMed] [Google Scholar]
- Perkins ES. Глазной токсоплазмоз. Бр Дж Офтальмол. 1973 г., январь; 57 (1): 1–17. [Бесплатная статья PMC] [PubMed] [Google Scholar]
- BENJAMIN B, BRICKMAN HF, NEAGA A.Врожденный токсоплазмоз у близнецов. Can Med Assoc J. 15 апреля 1958 г .; 80 (8): 639–643. [Бесплатная статья PMC] [PubMed] [Google Scholar]
- BEVERLEY JK. Врожденные токсоплазменные инфекции. Proc R Soc Med. 1960, февраль; 53: 111–113. [Бесплатная статья PMC] [PubMed] [Google Scholar]
- Sunness JS. Глаз беременной женщины.
 Сурв Офтальмол. 1988 г., январь-февраль; 32 (4): 219–238. [PubMed] [Google Scholar]
Сурв Офтальмол. 1988 г., январь-февраль; 32 (4): 219–238. [PubMed] [Google Scholar] - LANGER H. Повторная врожденная инфекция токсоплазмой гондии. Акушерство Гинекол. 1963 март; 21: 318–329.[PubMed] [Google Scholar]
- Юкинс Р.Э., Винтер ФК. Поражение глаз при врожденном токсоплазмозе у разнояйцевых близнецов. Am J Офтальмол. 1966 г., июль; 62 (1): 44–46. [PubMed] [Google Scholar]
- Аван К.Дж. Врожденный токсоплазмоз: вероятность возникновения у последующих братьев и сестер. Энн Офтальмол. 1978 г., апрель; 10 (4): 459–465. [PubMed] [Google Scholar]
- Gump DW, Holden RA. Приобретенный хориоретинит вследствие токсоплазмоза. Энн Интерн Мед. 1979 г., январь; 90 (1): 58–60. [PubMed] [Google Scholar]
- Саари М., Вуорре И., Нейминен Х., Райсанен С.Приобретенный токсоплазматический хориоретинит. Арка Офтальмол. 1976 г., сен; 94 (9): 1485–1488. [PubMed] [Google Scholar]
- Мазур Х., Джонс Т.С., Лемперт Дж.А., Черубини Т.Д. Вспышка токсоплазмоза в семье и документация приобретенного ретинохориоидита.
 Am J Med. 1978 г., март; 64 (3): 396–402. [PubMed] [Google Scholar]
Am J Med. 1978 г., март; 64 (3): 396–402. [PubMed] [Google Scholar] - Silveira C, Belfort R, Jr, Burnier M, Jr, Nussenblatt R. Приобретенная токсоплазматическая инфекция как причина токсоплазматического ретинохориоидита в семьях. Am J Офтальмол. 1988 г., 15 сентября; 106 (3): 362–364.[PubMed] [Google Scholar]
- Ferguson DJ, Hutchison WM. Взаимоотношения хозяина и паразита Toxoplasma gondii в мозге хронически инфицированных мышей. Арка Вирхова А Патол Анат Гистопатол. 1987;411(1):39–43. [PubMed] [Google Scholar]
- LAINSON R. Наблюдения за развитием и природой псевдокист и кист Toxoplasma gondii. Trans R Soc Trop Med Hyg. 1958 г., сен; 52 (5): 396–407. [PubMed] [Google Scholar]
- Hoff RL, Dubey JP, Behbehani AM, Frenkel JK. Кисты Toxoplasma gondii в культуре клеток: новые биологические данные.J Паразитол. 1977 г., декабрь; 63 (6): 1121–1124. [PubMed] [Google Scholar]
- Jones TC, Bienz KA, Erb P. Культивирование in vitro цист Toxoplasma gondii в астроцитах в присутствии гамма-интерферона.
 Заразить иммун. 1986 г., январь; 51 (1): 147–156. [Бесплатная статья PMC] [PubMed] [Google Scholar]
Заразить иммун. 1986 г., январь; 51 (1): 147–156. [Бесплатная статья PMC] [PubMed] [Google Scholar] - Tadros W, Laarman JJ. Современные представления о биологии, эволюции и таксономии тканевых цистообразующих эймериидных кокцидий. Ад Паразитол. 1982; 20: 293–468. [PubMed] [Google Scholar]
- Ferguson DJ, Hutchison WM, Pettersen E.Разрыв кисты ткани у мышей, хронически инфицированных Toxoplasma gondii. Иммуноцитохимическое и ультраструктурное исследование. Паразитол рез. 1989;75(8):599–603. [PubMed] [Google Scholar]
- Frenkel JK, Escajadillo A. Разрыв кисты как патогенный механизм токсоплазматического энцефалита. Am J Trop Med Hyg. 1987 г., май; 36 (3): 517–522. [PubMed] [Google Scholar]
- ФРЕНКЕЛЬ Дж.К. Поражение глаз у хомяков; с хронической токсоплазменной и бесноитиозной инфекцией. Am J Офтальмол. 1955 г., февраль; 39 (2 часть 2): 203–225.[PubMed] [Google Scholar]
- Nussenblatt RB, Gery I, Ballintine EJ, Wacker WB. Клеточный иммунный ответ больных увеитом на S-антиген сетчатки.
 Am J Офтальмол. 1980 г., февраль; 89 (2): 173–179. [PubMed] [Google Scholar]
Am J Офтальмол. 1980 г., февраль; 89 (2): 173–179. [PubMed] [Google Scholar] - БЕВЕРЛИ Дж. К. Рациональный подход к лечению токсоплазматического увеита. Trans Opthal Soc U K. 1958; 78: 109–121. [PubMed] [Google Scholar]
- Ferguson DJ, Hutchison WM. Ультраструктурное исследование раннего развития и образования тканевых кист Toxoplasma gondii в головном мозге мышей.Паразитол рез. 1987;73(6):483–491. [PubMed] [Google Scholar]
- Pavesio CE, Chiappino ML, Setzer PY, Nichols BA. Toxoplasma gondii: дифференцировка и гибель брадизоитов. Паразитол рез. 1992;78(1):1–9. [PubMed] [Google Scholar]
- Акштейн Р.Б., Уилсон Л.А., Тойч С.М. Приобретенный токсоплазмоз. Офтальмология. 1982 г., декабрь; 89 (12): 1299–1302. [PubMed] [Google Scholar]
- HOGAN MJ. Глазной токсоплазмоз. Am J Офтальмол. 1958 г., октябрь; 46 (4): 467–494. [PubMed] [Google Scholar]
- BERENGO A, FREZZOTTI R.Активный нейроофтальмологический токсоплазмоз. Клиническое исследование девятнадцати пациентов.
 Библ Офтальмол. 1962; 59: 265–343. [PubMed] [Google Scholar]
Библ Офтальмол. 1962; 59: 265–343. [PubMed] [Google Scholar] - Friedmann CT, Knox DL. Вариации рецидивирующего активного токсоплазматического ретинохориоидита. Арка Офтальмол. 1969 г., апрель; 81 (4): 481–493. [PubMed] [Google Scholar]
- Doft BH, Gass DM. Точечный наружный токсоплазмоз сетчатки. Арка Офтальмол. 1985 г., сен; 103 (9): 1332–1336. [PubMed] [Google Scholar]
- Matthews JD, Weiter JJ. Наружный токсоплазмоз сетчатки.Офтальмология. 1988 г., июль; 95 (7): 941–946. [PubMed] [Google Scholar]
- Silveira C, Belfort R, Jr, Nussenblatt R, Farah M, Takahashi W, Imamura P, Burnier M., Jr Односторонняя пигментная ретинопатия, связанная с глазным токсоплазмозом. Am J Офтальмол. 1989 г., 15 июня; 107 (6): 682–684. [PubMed] [Google Scholar]
- O’Connor GR. Проявления и лечение глазного токсоплазмоза. Бюлл. Н.Ю. акад. мед. 1974 г., февраль; 50 (2): 192–210. [Бесплатная статья PMC] [PubMed] [Google Scholar]
- Rehder JR, Burnier MB, Jr, Pavesio CE, Kim MK, Rigueiro M, Petrilli AM, Belfort R.
 , Jr Острый односторонний токсоплазматический иридоциклит у больного СПИДом. Am J Офтальмол. 1988 г., 15 декабря; 106 (6): 740–741. [PubMed] [Google Scholar]
, Jr Острый односторонний токсоплазматический иридоциклит у больного СПИДом. Am J Офтальмол. 1988 г., 15 декабря; 106 (6): 740–741. [PubMed] [Google Scholar] - ZIMMERMAN LE. Патология демиелинизирующих заболеваний. Trans Am Acad Офтальмол Отоларингол. 1956 г., январь-февраль; 60 (1): 46–58. [PubMed] [Google Scholar]
- HOGAN MJ, KIMURA SJ, O’CONNOR GR. ГЛАЗНОЙ ТОКСОПЛАЗМОЗ. Арка Офтальмол. 1964 г., ноябрь; 72: 592–600. [PubMed] [Google Scholar]
- Chesterton JR, Perkins ES. Глазной токсоплазмоз среди негритянских иммигрантов в Лондоне.Бр Дж Офтальмол. 1967 г., сен; 51 (9): 617–621. [Бесплатная статья PMC] [PubMed] [Google Scholar]
- Толедо де Абреу М., Белфорт Р., младший, Хирата П.С. Гетерохромный циклит Фукса и глазной токсоплазмоз. Am J Офтальмол. 1982 г., июнь; 93 (6): 739–744. [PubMed] [Google Scholar]
- Arffa RC, Schlaegel TF., Jr Хориоретинальные рубцы при гетерохромном иридоциклите Фукса. Арка Офтальмол. 1984 г., август; 102 (8): 1153–1155.
 [PubMed] [Google Scholar]
[PubMed] [Google Scholar] - La Hey E, Rothova A, Baarsma GS, de Vries J, van Knapen F, Kijlstra A.Гетерохромный иридоциклит Фукса не связан с глазным токсоплазмозом. Арка Офтальмол. 1992 г., июнь; 110 (6): 806–811. [PubMed] [Google Scholar]
- WILDER HC. Токсоплазменный хориоретинит у взрослых. AMA Arch Офтальмол. 1952 г., август; 48 (2): 127–136. [PubMed] [Google Scholar]
- Schuman JS, Weinberg RS, Ferry AP, Guerry RK. Токсоплазматический склерит. Офтальмология. 1988 г., октябрь; 95 (10): 1399–1403. [PubMed] [Google Scholar]
- Браунштейн Р.А., Гасс Д.Д. Обструкция ветвей артерии, вызванная острым токсоплазмозом.Арка Офтальмол. 1980 март; 98 (3): 512–513. [PubMed] [Google Scholar]
- Уиллерсон Д., младший, Ааберг Т.М., Ризер Ф., Мередит Т.А. Необычная глазная картина острого токсоплазмоза. Бр Дж Офтальмол. 1977 г., ноябрь; 61 (11): 693–698. [Бесплатная статья PMC] [PubMed] [Google Scholar]
- Morgan CM, Gragoudas ES. Окклюзия ветви артерии сетчатки, связанная с рецидивирующим токсоплазматическим ретинохориоидитом.
 Арка Офтальмол. 1987 г., январь; 105 (1): 130–131. [PubMed] [Google Scholar]
Арка Офтальмол. 1987 г., январь; 105 (1): 130–131. [PubMed] [Google Scholar] - Fine SL, Owens SL, Haller JA, Knox DL, Patz A.Хориоидальная неоваскуляризация как позднее осложнение глазного токсоплазмоза. Am J Офтальмол. 1981 март; 91 (3): 318–322. [PubMed] [Google Scholar]
- Skorska I, Soubrane G, Coscas G. Choroïdite toxoplasmique et néo-vaisseaux sous-rétiniens. J Fr Офтальмол. 1984;7(3):211–218. [PubMed] [Google Scholar]
- Леви Р.М., Розенблум С., Перретт Л.В. Нейрорадиологические данные при СПИДе: обзор 200 случаев. AJR Am J Рентгенол. 1986 г., ноябрь; 147 (5): 977–983. [PubMed] [Google Scholar]
- Вонг Б., Голд Дж.В., Браун А.Е., Ланге М., Фрид Р., Грико М., Милдван Д., Гирон Дж., Таппер М.Л., Лернер К.В. и др.Токсоплазмоз центральной нервной системы у гомосексуальных мужчин и парентеральных наркоманов. Энн Интерн Мед. 1984 г., январь; 100 (1): 36–42. [PubMed] [Google Scholar]
- Хоффлин Дж. М., Конли Ф. К., Ремингтон Дж. С. Мышиная модель внутримозгового токсоплазмоза.
 J заразить Dis. 1987 г., март; 155 (3): 550–557. [PubMed] [Google Scholar]
J заразить Dis. 1987 г., март; 155 (3): 550–557. [PubMed] [Google Scholar] - Luft BJ, Remington JS. Комментарий о СПИДе. Токсоплазматический энцефалит. J заразить Dis. 1988 г., январь; 157 (1): 1–6. [PubMed] [Google Scholar]
- McCabe R, Remington JS. Токсоплазмоз: время пришло.N Engl J Med. 1988 г., 4 февраля; 318 (5): 313–315. [PubMed] [Google Scholar]
- Kovacs JA. Эффективность атоваквона в лечении токсоплазмоза у больных СПИДом. Очная программа СПИДа НИАИД-Клинический центр. Ланцет. 1992 г., 12 сентября; 340 (8820): 637–638. [PubMed] [Google Scholar]
- Вайс А., Марго К.Э., Ледфорд Д.К., Локки Р.Ф., Бринсер Дж.Х. Токсоплазматический ретинохориоидит как начальное проявление синдрома приобретенного иммунодефицита. Am J Офтальмол. 1986 г., 15 февраля; 101 (2): 248–249. [PubMed] [Google Scholar]
- Parke DW, 2nd, Font RL.Диффузный токсоплазматический ретинохориоидит у больного СПИДом. Арка Офтальмол. 1986 г., апрель; 104 (4): 571–575. [PubMed] [Google Scholar]
- Holland GN, Engstrom RE, Jr, Glasgow BJ, Berger BB, Daniels SA, Sidikaro Y, Harmon JA, Fischer DH, Boyer DS, Rao NA, et al.
 Глазной токсоплазмоз у больных с синдромом приобретенного иммунодефицита. Am J Офтальмол. 1988 г., 15 декабря; 106 (6): 653–667. [PubMed] [Google Scholar]
Глазной токсоплазмоз у больных с синдромом приобретенного иммунодефицита. Am J Офтальмол. 1988 г., 15 декабря; 106 (6): 653–667. [PubMed] [Google Scholar] - Cochereau-Massin I, LeHoang P, Lautier-Frau M, Zerdoun E, Zazoun L, Robinet M, Marcel P, Girard B, Katlama C, Leport C, et al.Токсоплазмоз глаз у больных, инфицированных вирусом иммунодефицита человека. Am J Офтальмол. 1992 г., 15 августа; 114 (2): 130–135. [PubMed] [Google Scholar]
- Berger BB, Egwuagu CE, Freeman WR, Wiley CA. Милиарный токсоплазматический ретинит при синдроме приобретенного иммунодефицита. Арка Офтальмол. 1993 г., март; 111 (3): 373–376. [PubMed] [Google Scholar]
- Мурти Р.С., Смит Р.Э., Рао Н.А. Прогрессирующий токсоплазмоз глаз у больных с синдромом приобретенного иммунодефицита. Am J Офтальмол. 1993 г., 15 июня; 115 (6): 742–747.[PubMed] [Google Scholar]
- Хорни Б., Валлат М., Дюран М., Песме Д. Токсоплазмоз глаз и болезнь Ходжкина: отчет о двух случаях. Арка Офтальмол. 1978 г.
 , январь; 96 (1): 62–63. [PubMed] [Google Scholar]
, январь; 96 (1): 62–63. [PubMed] [Google Scholar] - Yeo JH, Jakobec FA, Iwamoto T, Richard G, Kreissig I. Оппортунистический токсоплазматический ретинохориоидит после химиотерапии системной лимфомы. Световое и электронно-микроскопическое исследование. Офтальмология. 1983 г., август; 90 (8): 885–898. [PubMed] [Google Scholar]
- Smith RE. Токсоплазматический ретинохориоидит как новая проблема у больных СПИДом.Am J Офтальмол. 1988 г., 15 декабря; 106 (6): 738–739. [PubMed] [Google Scholar]
- Holland GN. Глазной токсоплазмоз у хозяина с ослабленным иммунитетом. Инт офтальмол. 1989 г., декабрь; 13 (6): 399–402. [PubMed] [Google Scholar]
Статьи из The British Journal of Ophthalmology предоставлены здесь с разрешения BMJ Publishing Group
Статья о токсоплазмозе
Непрерывное образование
Токсоплазмоз вызывается паразитом Toxoplasma gondii, облигатным внутриклеточным простейшим. Хотя во всем мире инфицировано много людей, это заболевание встречается редко, поскольку большинство инфекций у людей протекает бессимптомно. Однако это распространенная оппортунистическая инфекция среди пациентов с ВИЧ/СПИДом и среди пациентов, перенесших трансплантацию органов. В этом мероприятии рассматриваются патогенез, оценка и лечение токсоплазмозной инфекции, а также подчеркивается роль межпрофессиональной команды в уходе за пациентами с этим заболеванием.
Хотя во всем мире инфицировано много людей, это заболевание встречается редко, поскольку большинство инфекций у людей протекает бессимптомно. Однако это распространенная оппортунистическая инфекция среди пациентов с ВИЧ/СПИДом и среди пациентов, перенесших трансплантацию органов. В этом мероприятии рассматриваются патогенез, оценка и лечение токсоплазмозной инфекции, а также подчеркивается роль межпрофессиональной команды в уходе за пациентами с этим заболеванием.
Цели:
- Определите этиологию и эпидемиологию токсоплазмоза.
- Опишите патофизиологию и роль клеточного иммунитета в развитии токсоплазмоза.
- Обзор терапевтического лечения токсоплазмоза.
- Обобщите важность координации межпрофессиональной команды для улучшения лечения токсоплазмоза и улучшения результатов лечения пациентов.

Введение
Токсоплазмоз вызывается паразитом Toxoplasma gondii , облигатным внутриклеточным простейшим.Хотя во всем мире инфицировано много людей, это заболевание встречается редко, поскольку большинство инфекций у людей протекает бессимптомно. Тем не менее, этот микроорганизм может вызывать серьезное заболевание у младенцев и лиц с ослабленным иммунитетом в результате первичной инфекции или реактивации латентной инфекции. Передача инфекции часто происходит при проглатывании тканевых цист через неправильно приготовленное/сырое мясо или проглатывании ооцист через зараженную пищу и воду. Также может происходить вертикальная передача и передача через трансплантацию органов.Лечение показано всем пациентам с ослабленным иммунитетом, а также иммунокомпетентным пациентам с тяжелыми симптомами. Комбинация пириметамина и сульфадиазина является предпочтительной схемой терапевтического лечения токсоплазмоза.
Этиология
T. gondii — облигатный внутриклеточный паразит, поражающий теплокровных животных, включая человека. У него сложный жизненный цикл, требующий окончательного хозяина и промежуточного хозяина для завершения полового и бесполого циклов соответственно.Члены семейства Felidae являются единственными известными окончательными хозяевами этого организма. Кошки могут заразиться при проглатывании инфицированных ооцист или тканевых цист через потребление промежуточных хозяев. Зараженные кошки выделяют миллионы неспорулированных ооцист с фекалиями в течение примерно 1–3 недель. Ооцистам требуется от 1 до 5 дней, чтобы превратиться в инфекционные ооцисты, которые могут оставаться инфекционными в окружающей среде около года.
gondii — облигатный внутриклеточный паразит, поражающий теплокровных животных, включая человека. У него сложный жизненный цикл, требующий окончательного хозяина и промежуточного хозяина для завершения полового и бесполого циклов соответственно.Члены семейства Felidae являются единственными известными окончательными хозяевами этого организма. Кошки могут заразиться при проглатывании инфицированных ооцист или тканевых цист через потребление промежуточных хозяев. Зараженные кошки выделяют миллионы неспорулированных ооцист с фекалиями в течение примерно 1–3 недель. Ооцистам требуется от 1 до 5 дней, чтобы превратиться в инфекционные ооцисты, которые могут оставаться инфекционными в окружающей среде около года.
При проглатывании неправильно приготовленного мяса или пищи, загрязненной кошачьими фекалиями, внешняя стенка кисты, окружающая спорозоиты и брадизоиты, протеолизируется желудочным соком в пищеварительном канале.Эти непокрытые спорозоиты и брадизоиты попадают в эпителий кишечника и дифференцируются в тахизоиты. Тахизоиты представляют собой быстро размножающиеся формы T. gondii . Тахизоиты могут проникать в любую ядросодержащую клетку, включая дендритные клетки, моноциты и нейтрофилы, что приводит к диссеминации. С началом иммунного ответа хозяина эти тахизоиты подавляются и в конечном итоге превращаются в медленно реплицирующиеся формы, называемые брадизоитами. Брадизоиты образуют вокруг себя толстую стенку кисты, образуя тканевую кисту, вмещающую тысячи брадизоитов.Эти кисты остаются в неактивной форме у иммунокомпетентного хозяина. Однако они могут реактивироваться, когда иммунная система хозяина скомпрометирована.
Тахизоиты представляют собой быстро размножающиеся формы T. gondii . Тахизоиты могут проникать в любую ядросодержащую клетку, включая дендритные клетки, моноциты и нейтрофилы, что приводит к диссеминации. С началом иммунного ответа хозяина эти тахизоиты подавляются и в конечном итоге превращаются в медленно реплицирующиеся формы, называемые брадизоитами. Брадизоиты образуют вокруг себя толстую стенку кисты, образуя тканевую кисту, вмещающую тысячи брадизоитов.Эти кисты остаются в неактивной форме у иммунокомпетентного хозяина. Однако они могут реактивироваться, когда иммунная система хозяина скомпрометирована.
Люди могут заразиться инфекцией T. gondii четырьмя способами:[1]
- Пищевой путь передачи — проглатывание тканевых цист при употреблении недоваренного/сырого мяса
- Зоонозная передача — Проглатывание ооцист при употреблении пищи и воды, загрязненных кошачьими фекалиями.
- Вертикальная передача — Инфицированная мать вызывает врожденную инфекцию через плаценту.

- Передача через трансплантацию органов или переливание крови.
Эпидемиология
По данным Центра по контролю и профилактике заболеваний (CDC), более 11% населения старше 6 лет инфицированы T. gondii в США.[2] Токсоплазмоз является основной причиной смерти от инфекций пищевого происхождения и является одной из пяти забытых паразитарных инфекций в Соединенных Штатах (наряду с болезнью Шагаса, трихомониазом, токсокарозом и цистицеркозом).Распространенность инфекции варьируется как между странами, так и локально внутри страны. Различные факторы, влияющие на распространенность, включают:
- Высокая распространенность T. gondii наблюдается в теплых и влажных районах, поскольку ооцисты лучше выживают в этих условиях.
- Участки с домашним скотом, поскольку они могут быть прямым источником инфекции и возможным резервуаром.[3]
- Серопревалентность увеличивается с возрастом.[4]
Факторы, влияющие на распространенность токсоплазмоза у пациентов с вирусом иммунодефицита человека (ВИЧ) и синдромом приобретенного иммунодефицита (СПИД), аналогичны факторам населения в целом. Пациенты со СПИДом подвержены риску развития реактивации заболевания, особенно когда количество CD4 падает ниже 100 клеток/мкл.
Пациенты со СПИДом подвержены риску развития реактивации заболевания, особенно когда количество CD4 падает ниже 100 клеток/мкл.
Патофизиология
Внутриклеточный рост тахизоитов приводит к прямым цитопатическим эффектам, клеточному воспалению и некрозу. Клеточный иммунитет типа 1 (CMI) в основном необходим для борьбы с острой и хронической инфекцией T. gondii. Таким образом, любые дефекты клеточного иммунитета предрасполагают хозяина к развитию тяжелых проявлений токсоплазмоза.В ответ на повреждение, вызванное проникновением тахизоита, эпителиальные клетки кишечника продуцируют хемокины, которые действуют как химические мессенджеры, что приводит к привлечению дендритных клеток (ДК), макрофагов и нейтрофилов к месту повреждения. Попадание тахизоитов в эти воспалительные клетки стимулирует выработку интерлейкина-12 (ИЛ-12). ИЛ-12 индуцирует синтез интерферона-гамма (ИФН-гамма) естественными киллерами (NK) и Т-лимфоцитами.
Синтез гамма-интерферона необходим для борьбы с острой и хронической инфекцией.Низкое количество CD4, наблюдаемое у больных СПИДом, приводит к более низким уровням IFN-гамма, вызывая тем самым беспрепятственное размножение тахизоитов при острой инфекции и реактивацию брадизоитов при латентной инфекции, что приводит к тяжелому заболеванию (церебральный и экстрацеребральный токсоплазмоз). Хотя CMI играет ключевую роль в контроле инфекции T. gondii , гуморальный иммунитет также способствует синтезу антител, модулированию ответов Т-клеток CD4 и CD8 и усилению продукции IFN-gamma, связанной с CMI.[4]
Гистопатология
Пациенты с токсоплазмозом часто имеют шейную и/или генерализованную лимфаденопатию, церебральный энцефалит и глазной токсоплазмоз. Гистологические находки часто поражаемых внутренних органов обсуждаются ниже:
- Биопсия лимфатических узлов. Триада фолликулярной гиперплазии, микрогранулем и моноцитоидной В-клеточной гиперплазии высокоспецифична для инфекции T.
 gondii .[5]
gondii .[5] - Биопсия головного мозга. Гистология обычно выявляет участки некроза с пятнистым диффузным энцефалитом, кисты, микроглиальные узелки, гранулемы и лимфоцитарный васкулит.[6]
- Биопсия глаза. Характеризуется некрозом на фоне сегментарного панофтальмита с ассоциированными тканевыми кистами и тахизоитами.[7]
Окрашивание ткани гематоксилином и эозином демонстрирует T. gondii паразитов (либо в форме тахизоитов, либо в тканевых цистах) как в здоровых, так и в некротизированных областях.Часто отмечалось, что они располагаются ближе к кровеносным сосудам, что указывает на гематогенное распространение инфекции.[7]
История и физика
Многие пациенты, инфицированные T. gondii , не имеют симптомов. Однако некоторые иммунокомпетентные пациенты с острой инфекцией могут жаловаться на нечеткие симптомы, включая лихорадку, озноб, головные боли, фарингит, миалгии, сыпь или гепатоспленомегалию. Чаще пациенты могут жаловаться на безболезненную шейную лимфаденопатию, которая может сохраняться в течение нескольких недель.[8] У иммунокомпетентных лиц с лихорадкой и шейной лимфаденопатией следует заподозрить токсоплазмоз.
Чаще пациенты могут жаловаться на безболезненную шейную лимфаденопатию, которая может сохраняться в течение нескольких недель.[8] У иммунокомпетентных лиц с лихорадкой и шейной лимфаденопатией следует заподозрить токсоплазмоз.
У лиц с ослабленным иммунитетом и тяжелыми осложнениями могут проявляться признаки и симптомы, связанные с пораженным органом. У ВИЧ-инфицированных пациентов обычно проявляются неврологические симптомы, хотя могут возникать и экстрацеребральные заболевания.
- Церебральный токсоплазмоз обычно проявляется неврологическими симптомами в зависимости от пораженной области мозга и количества поражений.Симптомы могут включать лихорадку, судороги, головные боли, изменение зрения, измененное психическое состояние, очаговый неврологический дефицит, когнитивную дисфункцию, атаксию и непроизвольные движения.[9]
- Внемозговой токсоплазмоз обычно проявляется пневмонитом и хориоретинитом; однако также могут возникать заболевания сердца, желудочно-кишечного тракта, мочеполовой системы, опорно-двигательного аппарата и диссеминированные заболевания.

- Пневмонит — у пациентов проявляются лихорадка, кашель и одышка
- Хориоретинит — у пациентов могут наблюдаться изменения зрения, плавающие мушки или боль в глазах.
Оценка
Хотя биопсия позволяет поставить окончательный диагноз, токсоплазмоз можно диагностировать на основании неинвазивных тестов, включая лабораторные исследования и визуализацию.
- Серологическое исследование. Это основной диагностический метод для определения инфекции Toxoplasma путем выявления антител IgM и IgG. Антитела IgM обычно обнаруживаются с 5-го дня после заражения, достигая максимального уровня через 1–2 месяца.Антитела IgG обнаруживаются через 1–2 недели после заражения, достигая максимального уровня через 3–6 месяцев. Toxoplasma Тестирование на антитела IgM не является специфичным; таким образом, серологию может быть трудно интерпретировать.
- Молекулярное тестирование — T.
 gondii ДНК можно обнаружить с помощью полимеразной цепной реакции (ПЦР) в крови и других жидкостях организма.
gondii ДНК можно обнаружить с помощью полимеразной цепной реакции (ПЦР) в крови и других жидкостях организма. - Рентгенологический диагноз. Результаты компьютерной томографии (КТ) или магнитно-резонансной томографии (МРТ) показывают множественные гиподенсивные области с кольцевидными очагами в головном мозге.Минимальные воспалительные изменения, наблюдаемые на ранних стадиях, могут быть плохо видны на КТ; таким образом, МРТ предпочтительнее КТ для диагностики поражений головного мозга при церебральном токсоплазмозе. Однофотонная эмиссионная КТ или позитронно-эмиссионная томография (ПЭТ) обладают высокой специфичностью, позволяющей исключить дифференциальный диагноз.
- Биопсия. Хотя это позволяет поставить окончательный диагноз путем выявления тахизоитов и тканевых кист T. gondii , обычно это не проводится. Биопсия показана для исключения других дифференциальных диагнозов у лиц, не демонстрирующих клинического или рентгенологического улучшения симптомов в течение 14 дней после начала терапии.

Лечение/управление
Целью лечения является ограничение размножения паразита во время активной инфекции. Терапевтическое лечение показано иммунокомпетентным лицам с тяжелыми или длительными симптомами, а также всем пациентам с ослабленным иммунитетом. В случаях подозрения на инфекцию T. gondii предпочтительнее эмпирическая терапия, основанная на предположительном диагнозе, чем ожидание результатов анализов. Комбинация пириметамина (нагрузочная доза 200 мг, затем 50 мг в день для пациентов <60 кг и 75 мг в день для пациентов >60 кг) и сульфадиазина (1000 мг четыре раза в день для пациентов <60 кг и 1500 мг четыре раза в день для пациентов >60 кг) является предпочтительной. схема лечения.Начальную терапию следует продолжать в течение 6 недель, после чего следует постоянная поддерживающая терапия.
Фолиевую кислоту обычно добавляют в схему лечения для предотвращения дефицита фолиевой кислоты, вызванного сульфадиазином. Стероиды добавляются к стандартной схеме лечения пациентов с отеком головного мозга и токсоплазмозом глаз. [10][11] Терапевтическое лечение токсоплазмоза также включает начало антиретровирусной терапии для восстановления иммунитета, обычно в течение 2 недель после начала терапии против токсоплазмоза.[12]
[10][11] Терапевтическое лечение токсоплазмоза также включает начало антиретровирусной терапии для восстановления иммунитета, обычно в течение 2 недель после начала терапии против токсоплазмоза.[12]
Профилактическую антитоксоплазменную терапию начинают у пациентов с ВИЧ/СПИДом, которые являются T. gondii IgG положительными с числом клеток CD4 <100 клеток/мкл. Триметоприм-сульфаметоксазол является препаратом выбора для предотвращения реактивации латентной инфекции. Профилактика может быть прекращена, когда количество CD4 > 200 клеток/мкл в течение не менее 3 месяцев и вирусная нагрузка подавлена.
Дифференциальная диагностика
- Лимфома ЦНС
- Метастатические поражения головного мозга
- Прогрессирующая многоочаговая энцефалопатия
- Туберкулез головного мозга
- Бактериальный/грибковый абсцесс головного мозга
- Цитомегаловирус
- Острая ВИЧ-инфекция
- Герпетический энцефалит
Прогноз
Острый токсоплазмоз обычно проходит самостоятельно у иммунокомпетентных лиц. Прогноз отличный без каких-либо долгосрочных последствий инфекции. Ранняя диагностика и начало эмпирического лечения, а также антиретровирусная терапия у пациентов со СПИДом улучшают результаты у лиц с иммуносупрессией.
Прогноз отличный без каких-либо долгосрочных последствий инфекции. Ранняя диагностика и начало эмпирического лечения, а также антиретровирусная терапия у пациентов со СПИДом улучшают результаты у лиц с иммуносупрессией.
Осложнения
Токсоплазмоз может вызывать тяжелые опасные для жизни осложнения у лиц с ослабленным иммунитетом, проявляющиеся токсоплазматическим энцефалитом или экстрацеребральным токсоплазмозом. Начало лечения может осложниться воспалительным синдромом восстановления иммунитета (ВСВИ), что приводит к парадоксальному ухудшению симптомов.Лечение включает продолжение противоинфекционной терапии, антиретровирусную терапию и начало приема стероидов (или увеличение дозы, если пациенты уже принимают стероиды).
Сдерживание и обучение пациентов
Было показано, что в некоторых частях мира инфицирование токсоплазмой превышает 60%, и, хотя первичные инфекции могут быть самоограничивающимися, существует риск более тяжелого течения заболевания при реактивации латентной инфекции. Пациенты могут снизить риск заражения следующим образом:
Пациенты могут снизить риск заражения следующим образом:
- Приготовление пищи при безопасных температурах или замораживание мяса в течение нескольких дней при отрицательных температурах перед приготовлением
- Тщательное мытье или очистка всех фруктов и овощей.
- Тщательное мытье поверхностей, соприкасавшихся с сырым мясом, птицей, морепродуктами и немытыми фруктами или овощами
- Отказ от непастеризованного козьего молока
- Ношение перчаток и выполнение надлежащей гигиены рук после контакта с лотками и после контакта с любым песком или землей, которые могли контактировать с кошачьими фекалиями.
Улучшение результатов работы команды здравоохранения
Подход межпрофессиональной бригады к оценке пациентов на токсоплазмоз может помочь в ранней диагностике и лечении.Учитывая высокую распространенность инфекции во всем мире, усилия по снижению первичной инфекции могут помочь предотвратить риск развития тяжелых заболеваний у людей в течение жизни. Кроме того, повышение осведомленности и просвещение в отношении использования профилактической терапии может помочь снизить частоту реактивации латентной инфекции.
Кроме того, повышение осведомленности и просвещение в отношении использования профилактической терапии может помочь снизить частоту реактивации латентной инфекции.
Toxoplasma gondii и рассеянный склероз: популяционное исследование случай-контроль
Мы обнаружили отрицательную связь между T.gondii и MS, предполагая возможную защитную роль этого паразита и поддерживая гигиеническую гипотезу. Согласно гигиенической гипотезе, низкий контакт с патогенами в раннем возрасте может увеличить риск аутоиммунных заболеваний, включая рассеянный склероз и аллергию, особенно в западных странах, вероятно, из-за иммунологического дисбаланса между Th2- и Th3-реакцией 4 .
Однако паразиты делятся на две основные группы: гельминты и простейшие, которые могут действовать с помощью различных иммунологических механизмов.Фактически, гельминты индуцируют Th3-ответ, характеризующийся продукцией IL-4, IL-5 и IL-10 17 , в то время как простейшие вызывают очень сильный Th2-ответ за счет продукции провоспалительных медиаторов, таких как IL-10. 12, IFN-γ и оксид азота 18 .
12, IFN-γ и оксид азота 18 .
Модуляция аутоиммунного ответа гельминтами была показана при различных аутоиммунных заболеваниях 19,20,21 . При РС защитное влияние гельминтов опосредовано подавлением воспалительных реакций и усилением иммунной регуляции 22 .Некоторые экспериментальные и эпидемиологические данные подтверждают эту гипотезу. В частности, было показано, что заражение Schistosoma mansoni оказывает защитное действие на развитие экспериментального аллергического энцефаломиелита (ЭАЭ) у инфицированных мышей, снижая продукцию и подавляя IFN-γ, фактор некроза опухоли альфа (TNF-α) и IL-12. классический ответ Th2 23 . Считается, что эти эффекты связаны с иммунологическим переключением на Th3-ответ, вызванным заражением паразитами 24 .
Помимо гельминтов, в последнее время интерес вызывает T. gondii , внутриклеточный паразит, вызывающий токсоплазмоз у людей и животных. Несколько исследований предположили связь между хронической инфекцией T. gondii и аутоиммунными заболеваниями, такими как сахарный диабет I типа, ревматоидный артрит и системная красная волчанка , , но были получены противоречивые результаты, предполагающие, что T. gondii может играть положительная или отрицательная роль в различных аутоиммунных состояниях 9,25,26 .
gondii и аутоиммунными заболеваниями, такими как сахарный диабет I типа, ревматоидный артрит и системная красная волчанка , , но были получены противоречивые результаты, предполагающие, что T. gondii может играть положительная или отрицательная роль в различных аутоиммунных состояниях 9,25,26 .
В последние годы в некоторых исследованиях изучалась связь между токсоплазмозом и рассеянным склерозом. Насколько нам известно, на сегодняшний день было проведено только пять исследований случай-контроль в больницах 26,27,28,29,30 и все, кроме одного 28 , сообщали об отрицательной связи , даже если бы оно было значимым только в двух исследованиях 27,29 . Тем не менее, следует отметить, что для большинства этих исследований размер выборки был очень маленьким, поэтому отсутствие значимости также может быть связано с отсутствием адекватной мощности.Только в одном исследовании 28 сообщалось о положительной, но незначительной связи между инфекцией T. gondii и РС, но и в этом случае размер выборки был особенно мал (52 пациента с РС и 45 контрольных) 28 . Все эти ранее проведенные исследования были включены в недавний метаанализ (669 пациентов с РС и 770 контрольных) 10 , где среди пациентов с РС была зарегистрирована более низкая совокупная серопревалентность T. gondii (32,4% по сравнению с 39.1%), что приводит к отрицательной, хотя и незначительной, связи с комбинированным ОШ 0,72 (95% ДИ: 0,49–1,06) 10 .
gondii и РС, но и в этом случае размер выборки был особенно мал (52 пациента с РС и 45 контрольных) 28 . Все эти ранее проведенные исследования были включены в недавний метаанализ (669 пациентов с РС и 770 контрольных) 10 , где среди пациентов с РС была зарегистрирована более низкая совокупная серопревалентность T. gondii (32,4% по сравнению с 39.1%), что приводит к отрицательной, хотя и незначительной, связи с комбинированным ОШ 0,72 (95% ДИ: 0,49–1,06) 10 .
Наше исследование представляет собой одно из крупнейших исследований случай-контроль, направленное на оценку возможной связи между T. gondii и рассеянным склерозом, и единственное с популяционным дизайном, позволяющим избежать возможной систематической ошибки отбора. В среднем серопревалентность, обнаруженная среди случаев (29,5%) и контрольной группы (45,4%), была близка к тем, о которых сообщалось в литературе 10 , со значительной отрицательной связью между T. gondii серопозитивен и MS с ОШ 0,50.
gondii серопозитивен и MS с ОШ 0,50.
Следует подчеркнуть, что, согласно литературным данным, мононуклеоз в анамнезе положительно связан с МС 22 . С другой стороны, наряду с серопозитивностью T. gondii , в нашей выборке также положительная история других аутоиммунных заболеваний была отрицательно связана с РС, что предполагает возможный защитный эффект. Даже если некоторые исследования указывают на повышенную частоту некоторых аутоиммунных заболеваний среди пациентов с РС, возможная связь между РС и другими аутоиммунными заболеваниями все еще обсуждается 31 .Однако следует отметить, что наличие аутоиммунного заболевания в нашем исследовании было основано только на клиническом анамнезе, поэтому этот вывод следует интерпретировать с осторожностью.
Принимая во внимание серопозитивность T. gondii , в соответствии с литературой, возраст и более низкий уровень образования представляют собой возможный фактор риска 8,32 , в то время как мы не обнаружили какой-либо значимой связи между владением домашним животным и серопозитивностью T. gondii . Кроме того, рассеянный склероз был связан с более высоким уровнем образования со значительной тенденцией, достигая OR 6.87 для тех, кто учился в университете 33,34 . Наоборот, более высокие уровни образования были связаны с более низкой распространенностью антител T. gondii к . Образование является косвенным показателем социально-экономического статуса, который, как правило, связан с повышенным уровнем санитарии и, таким образом, со сниженным воздействием различных патогенов в детстве. Эти данные также согласуются с гипотезой о гигиене, что подтверждается некоторыми первоначальными исследованиями рассеянного склероза, проведенными в 90-х годах 33,34 .
gondii . Кроме того, рассеянный склероз был связан с более высоким уровнем образования со значительной тенденцией, достигая OR 6.87 для тех, кто учился в университете 33,34 . Наоборот, более высокие уровни образования были связаны с более низкой распространенностью антител T. gondii к . Образование является косвенным показателем социально-экономического статуса, который, как правило, связан с повышенным уровнем санитарии и, таким образом, со сниженным воздействием различных патогенов в детстве. Эти данные также согласуются с гипотезой о гигиене, что подтверждается некоторыми первоначальными исследованиями рассеянного склероза, проведенными в 90-х годах 33,34 .
Наши данные подтверждают гипотезу о гигиене. Однако, что касается других простейших, следует отметить, что T. gondii вызывает очень сильный Th2-ответ, а не характерный Th3-ответ, наблюдаемый для гельминтов 35 . На самом деле литературные данные предполагают, что возможная защитная роль T. gondii может проявляться за счет увеличения продукции IL-10 35 . Действительно, исследования с использованием как человеческих, так и животных моделей позволили предположить ряд различных лежащих в основе механизмов.В частности, на животных моделях было продемонстрировано, что T. gondii не только индуцирует продукцию IFN-γ в T-bet + T-хелперных клетках, но и IL-10, что указывает на то, что паразит проявляет регуляторную активность в остром периоде. и хроническая фаза 9,35 . Согласно литературным данным IL-10 может играть важную роль в снижении аутоиммунной реакции при РС 36 , таким образом, что касается моделей гельминтов, можно предположить, что T.gondii может оказывать защитное действие за счет повышения уровня IL-10.
gondii может проявляться за счет увеличения продукции IL-10 35 . Действительно, исследования с использованием как человеческих, так и животных моделей позволили предположить ряд различных лежащих в основе механизмов.В частности, на животных моделях было продемонстрировано, что T. gondii не только индуцирует продукцию IFN-γ в T-bet + T-хелперных клетках, но и IL-10, что указывает на то, что паразит проявляет регуляторную активность в остром периоде. и хроническая фаза 9,35 . Согласно литературным данным IL-10 может играть важную роль в снижении аутоиммунной реакции при РС 36 , таким образом, что касается моделей гельминтов, можно предположить, что T.gondii может оказывать защитное действие за счет повышения уровня IL-10.
Более того, ответ хозяина на острую инфекцию токсоплазмоза характеризуется сильной воспалительной активацией, опосредованной лимфоцитами Th27 CD4, продуцирующими IL-17 37 . В свою очередь, T. gondii разработали механизмы выживания, которые обеспечивают выживание паразита за счет подавления ответа Th-17 за счет индукции продукции IL-27 антигенпрезентирующими клетками 37 .Интересно, что высокие уровни IL-27 были продемонстрированы в спинномозговой жидкости пациентов с рассеянным склерозом, вероятно, проявляя противовоспалительную активность 38 .
В свою очередь, T. gondii разработали механизмы выживания, которые обеспечивают выживание паразита за счет подавления ответа Th-17 за счет индукции продукции IL-27 антигенпрезентирующими клетками 37 .Интересно, что высокие уровни IL-27 были продемонстрированы в спинномозговой жидкости пациентов с рассеянным склерозом, вероятно, проявляя противовоспалительную активность 38 .
Другое возможное объяснение иммуносупрессивной активности инфекции T. gondii может быть связано с активацией FoxP3+ T-клеток, которые ослабляют ответ иммунной системы во время хронической инфекции T. gondii , вероятно, за счет снижения доступности IL- 2, сильный провоспалительный цитокин 39 .Наконец, также TGF-бета имеет отношение к иммуносупрессии, присутствующей во время хронической инфекции T. gondii 40 , цитокин, который играет важную роль в продвижении регуляторной активности CD4 у пациентов с РС 41 .
Тем не менее, на сегодняшний день нет данных об экспериментальной инфекции T. gondii у мышей с ЭАЭ, мышиной модели РС, поэтому необходимы исследования для понимания лежащих в основе патофизиологических механизмов .
gondii у мышей с ЭАЭ, мышиной модели РС, поэтому необходимы исследования для понимания лежащих в основе патофизиологических механизмов .
В попытке понять возможные подчеркивающие механизмы, которые могли бы объяснить взаимосвязь между паразитарными инфекциями и аутоиммунными заболеваниями, в предыдущем исследовании, включавшем ту же выборку пациентов и контролей, мы оценили связь между РС и Т.canis , один из самых распространенных гельминтозов в мире, но мы не обнаружили какой-либо значимой связи 16 .
С методологической точки зрения наши исследования обладают многими преимуществами. Это первое популяционное исследование случай-контроль, проведенное для оценки возможной связи между РС и T. gondii. Фактически, пациентов с РС были случайным образом отобраны из хорошо зарекомендовавшей себя когорты пациентов с РС, в то время как контрольная группа была отобрана из общей популяции с использованием метода многоэтапной выборки 11 , что снизило риск возможной систематической ошибки отбора среди случаев. Кроме того, наряду с исследованием, проведенным Stascheit и соавт. в 2015 году 27 наше исследование представляет собой крупнейшее исследование случай-контроль, проведенное для изучения возможной связи между РС и T. gondii .
Кроме того, наряду с исследованием, проведенным Stascheit и соавт. в 2015 году 27 наше исследование представляет собой крупнейшее исследование случай-контроль, проведенное для изучения возможной связи между РС и T. gondii .
Наряду с систематической ошибкой выбора, систематическая ошибка припоминания представляет собой второй наиболее распространенный тип систематической ошибки, влияющей на исследования случай-контроль. Однако в нашем исследовании возможная роль предвзятости отзыва может быть исключена, поскольку воздействие T. gondii оценивалось по обнаружению антител IgG в сыворотке, а биолог, проводивший серологическую оценку, был ослеплен в отношении статуса заболевания.
Тем не менее, ретроспективный характер схемы случай-контроль в значительной степени ограничивает интерпретацию наших результатов. Мы не можем исключить роль низкого социально-экономического статуса в модулировании взаимодействия между инфекцией T. gondii и РС, учитывая, что она действует как фактор риска для T. gondii и как защитный фактор для РС. Тем не менее, мы провели многомерную модель, включающую уровень образования и профессиональный статус, рассматриваемые как показатели социально-экономического статуса, и мы обнаружили все еще значительный защитный эффект T.gondii на MS. Более того, роль употребления в пищу сырого/недоваренного мяса и его связь с повышенным риском заражения T. gondii, не изучалась из-за отсутствия этой информации в исходном исследовании случай-контроль. В любом случае, хотя существует повышенный риск заражения T. gondii при употреблении сырого/недоваренного мяса 7 , связь между потреблением мяса и РС все еще неясна 42 .
gondii и как защитный фактор для РС. Тем не менее, мы провели многомерную модель, включающую уровень образования и профессиональный статус, рассматриваемые как показатели социально-экономического статуса, и мы обнаружили все еще значительный защитный эффект T.gondii на MS. Более того, роль употребления в пищу сырого/недоваренного мяса и его связь с повышенным риском заражения T. gondii, не изучалась из-за отсутствия этой информации в исходном исследовании случай-контроль. В любом случае, хотя существует повышенный риск заражения T. gondii при употреблении сырого/недоваренного мяса 7 , связь между потреблением мяса и РС все еще неясна 42 .
Действительно, мы не можем установить точную последовательность событий, поэтому мы не можем исключить, что экспозиция Т.gondii возник после начала заболевания. Тем не менее, следует подчеркнуть, что предыдущее исследование не обнаружило связи между длительностью заболевания и нагрузкой антителами 29 .
В заключение, даже если наше исследование подтверждает возможную защитную роль T. gondii при РС, необходимы дальнейшие клинические и экспериментальные исследования для подтверждения наших результатов и понимания основных патофизиологических механизмов 27 .
Токсоплазмоз-MSPCA-Angell
Дэвид Джимисон, DVM
Энджелл.орг/общая медицина
617-522-7282
Toxoplasma Gondii — это небольшой протозойный паразит, который чаще всего поражает наших кошачьих друзей. Клинические признаки токсоплазмоза у кошек в первую очередь проявляются в пораженной паразитом системе органов. Чаще всего мы видим либо отсутствие клинических признаков, либо умеренную лихорадку, вялость и желудочно-кишечные признаки, такие как диарея. Другие пораженные системы организма включают воспаление глаз, проблемы с дыханием, мышечные боли или неврологические заболевания с затруднениями при ходьбе или судорогами. Если вы обеспокоены тем, что у вашей кошки могут возникнуть какие-либо из этих проблем, связанных с токсоплазмозом, проконсультируйтесь с вашим ветеринаром для соответствующего ухода и лабораторных анализов.
Если вы обеспокоены тем, что у вашей кошки могут возникнуть какие-либо из этих проблем, связанных с токсоплазмозом, проконсультируйтесь с вашим ветеринаром для соответствующего ухода и лабораторных анализов.
Жизненный цикл
Кошки являются окончательным хозяином паразита Toxoplasma , где происходит размножение и репликация паразита. Хотя другие виды могут быть заражены токсоплазмой , паразит сможет завершить свой жизненный цикл только внутри кошки.После заражения Toxoplasma организм вступает в репродуктивную стадию и производит ооцисты (яйца), которые затем попадают в окружающую среду через кошачий стул. Выделение этих ооцист обычно длится несколько недель.
Попадая в окружающую среду, ооцисты Toxoplasma попадают в организм мелких животных, таких как грызуны, птицы или тараканы. Как видно на диаграмме CDC (Центры по контролю и профилактике заболеваний), большинство кошек могут затем заразиться при проглатывании этих мелких животных, называемых промежуточными хозяевами, и жизненный цикл повторяется. Поскольку в жизненном цикле чаще всего участвует этот промежуточный хозяин, токсоплазмоз чаще встречается у кошек, которые проводят всю или часть своей жизни на улице.
Поскольку в жизненном цикле чаще всего участвует этот промежуточный хозяин, токсоплазмоз чаще встречается у кошек, которые проводят всю или часть своей жизни на улице.
Здравоохранение
Toxoplasma считается зоонозным организмом, то есть может передаваться между животными и людьми. Хорошей новостью является то, что риск заражения человека низок, если приняты надлежащие меры предосторожности. Кроме того, у людей со здоровой иммунной системой токсоплазмоз обычно приводит к лихорадке, недомоганию и гриппоподобным симптомам, которые могут проходить самостоятельно.В редких случаях тяжелая инфекция может привести к повреждению глаз, дыхательных путей, головного мозга или других органов. Тяжелые реакции чаще встречаются у людей с ослабленной иммунной системой. Пожалуйста, проконсультируйтесь с врачом, если у вас есть опасения по поводу заражения человека этим паразитом.
Источники заражения человека токсоплазмозом включают:
- Проглатывание недоваренного мяса (особенно баранины, свинины или оленины).

- Проглатывание после контакта с недоваренным мясом и неправильным мытьем рук или неправильным мытьем столовых приборов, посуды, разделочных досок и т. д.
- Проглатывание после обращения с кошачьими фекалиями, например, после чистки кошачьего туалета или неправильного мытья рук.
- Проглатывание ооцист после работы в саду, где могут присутствовать кошачьи фекалии при неправильном мытье рук.
- Проглатывание немытых фруктов и овощей.
- Передача от матери к ребенку во время беременности.
В целях снижения риска инфицирования людей токсоплазмозом все мясо перед употреблением следует тщательно готовить. Очищайте или мойте все фрукты и овощи перед едой.Вымойте все разделочные доски, посуду, столовые приборы и т. д. после контакта с сырым или недоваренным мясом. Работая в саду или работая с кошачьими фекалиями, надевайте перчатки, после чего тщательно мойте руки. Регулярная очистка ящика для мусора также может помочь уменьшить передачу инфекции. Ооцисты Toxoplasma должны оставаться в окружающей среде не менее 24 часов, прежде чем они станут заразными. Таким образом, своевременная и регулярная очистка туалетного лотка предотвратит заражение любых ооцист, если они присутствуют. Надлежащая гигиена и приготовление пищи являются ключом к снижению риска передачи не только Toxoplasma , но и всех других пищевых патогенов.
Ооцисты Toxoplasma должны оставаться в окружающей среде не менее 24 часов, прежде чем они станут заразными. Таким образом, своевременная и регулярная очистка туалетного лотка предотвратит заражение любых ооцист, если они присутствуют. Надлежащая гигиена и приготовление пищи являются ключом к снижению риска передачи не только Toxoplasma , но и всех других пищевых патогенов.
Если вы планируете создать семью или расширить существующую семью и у вас есть вопросы или опасения по поводу риска заражения токсоплазмозом, проконсультируйтесь со своим врачом для получения рекомендаций по тестированию и профилактике. Некоторые люди задаются вопросом, безопасно ли держать кошку при ослабленном иммунитете или беременной. Вам не нужно отказываться от своего кошачьего компаньона. Соблюдая надлежащие меры предосторожности, вы можете предпринять шаги, чтобы значительно минимизировать риск заболевания. Во-первых, кошек следует держать в помещении, чтобы свести к минимуму заражение инфекционными организмами, такими как Toxoplasma , извне. Кошек следует кормить сбалансированным коммерческим кормом для кошек и избегать сырых кормов для кошек, которые могут содержать инфекционные заболевания. Следите за тем, чтобы лоток чистился ежедневно; паразиту Toxoplasma требуется около 1-5 дней, чтобы стать заразным после передачи от кошки. По возможности не меняйте лоток. Вы можете попросить супруга или члена семьи очистить лоток за вас. Если это не может сделать кто-то другой, обязательно наденьте одноразовые перчатки и тщательно вымойте руки после этого.
Кошек следует кормить сбалансированным коммерческим кормом для кошек и избегать сырых кормов для кошек, которые могут содержать инфекционные заболевания. Следите за тем, чтобы лоток чистился ежедневно; паразиту Toxoplasma требуется около 1-5 дней, чтобы стать заразным после передачи от кошки. По возможности не меняйте лоток. Вы можете попросить супруга или члена семьи очистить лоток за вас. Если это не может сделать кто-то другой, обязательно наденьте одноразовые перчатки и тщательно вымойте руки после этого.
Мы должны помнить, что, хотя кошки являются окончательным хозяином этого паразита и могут служить источником, их нельзя винить. Мы, как опекуны наших питомцев, можем взять на себя активную роль в ограничении воздействия, которое испытывают наши кошачьи компаньоны, и тем самым ограничивая наше личное воздействие. Соблюдая надлежащую гигиену, готовя еду и поддерживая окружающую среду, мы можем значительно снизить риск инфекционных заболеваний, чтобы защитить себя, свою семью и наших четвероногих друзей.
Токсоплазмоз — Симптомы и причины
Обзор
Токсоплазмоз (tok-so-plaz-MOE-sis) — заболевание, возникающее в результате заражения паразитом Toxoplasma gondii, одним из самых распространенных паразитов в мире. Заражение обычно происходит при употреблении в пищу недоваренного зараженного мяса, контакте с инфицированными фекалиями кошек или передаче от матери к ребенку во время беременности.
Токсоплазмоз у некоторых людей может вызывать гриппоподобные симптомы, но у большинства людей признаки и симптомы никогда не проявляются.У младенцев, рожденных инфицированными матерями, и у людей с ослабленной иммунной системой токсоплазмоз может вызывать серьезные осложнения.
Если вы в целом здоровы, не беременны и у вас диагностирован токсоплазмоз, вам, вероятно, не потребуется никакого лечения, кроме консервативного. Если вы беременны или имеете пониженный иммунитет, вам может потребоваться медикаментозное лечение, чтобы избежать серьезных осложнений. Однако лучший подход — это профилактика.
Однако лучший подход — это профилактика.
Симптомы
Большинство здоровых людей, инфицированных токсоплазмозом, не имеют признаков или симптомов и не осознают, что инфицированы.Однако у некоторых людей появляются признаки и симптомы, сходные с симптомами гриппа, в том числе:
- Боли в теле
- Увеличение лимфатических узлов
- Головная боль
- Лихорадка
- Усталость
У людей с ослабленной иммунной системой
Если у вас ВИЧ / СПИД , вы проходите курс химиотерапии или недавно перенесли трансплантацию органов, возможно реактивация предшествующей токсоплазменной инфекции. В этом случае у вас могут развиться более серьезные признаки и симптомы инфекции, в том числе:
- Головная боль
- Путаница
- Плохая координация
- Приступы
- Проблемы с легкими, которые могут напоминать туберкулез или пневмоцистную пневмонию Pneumocystis jiroveci, распространенную оппортунистическую инфекцию, которая возникает у людей с СПИДом
- Затуманенное зрение, вызванное тяжелым воспалением сетчатки (глазной токсоплазмоз)
У младенцев
Если вы впервые заразились непосредственно перед беременностью или во время нее, вы можете передать инфекцию своему ребенку (врожденный токсоплазмоз), даже если у вас самих нет признаков и симптомов.
Ваш ребенок подвергается наибольшему риску заражения токсоплазмозом, если вы заразитесь в третьем триместре, и наименьшему риску, если вы заразитесь в первом триместре. С другой стороны, чем раньше во время беременности происходит заражение, тем серьезнее последствия для вашего ребенка.
Многие ранние инфекции заканчиваются мертворождением или выкидышем. Младенцы, которые выживают, скорее всего, родятся с серьезными проблемами, такими как:
- Изъятия
- Увеличение печени и селезенки
- Пожелтение кожи и белков глаз (желтуха)
- Тяжелые глазные инфекции
Только у небольшого числа детей, больных токсоплазмозом, при рождении проявляются признаки заболевания.Часто у инфицированных младенцев не появляются признаки, которые могут включать потерю слуха, умственную отсталость или серьезные глазные инфекции, до подросткового возраста или позже.
Когда обратиться к врачу
Если вы живете с ВИЧ или СПИДом , беременны или думаете забеременеть, поговорите со своим врачом о сдаче анализов, если вы считаете, что могли подвергнуться воздействию токсоплазмоза.
Признаки и симптомы тяжелой формы токсоплазмоза — помутнение зрения, спутанность сознания, потеря координации — требуют немедленной медицинской помощи, особенно если ваша иммунная система ослаблена.
Возбудители
Toxoplasma gondii (T. gondii) представляет собой одноклеточный паразитический организм, который может инфицировать большинство животных и птиц. Поскольку инфекционные организмы T. gondii выделяются только с кошачьими фекалиями, дикие и домашние кошки являются конечными хозяевами паразита.
Хотя вы не можете «заразиться» токсоплазмозом от инфицированного ребенка или взрослого, вы можете заразиться, если вы:
- Контакт с кошачьими фекалиями, содержащими паразита. Вы можете случайно проглотить паразитов, если прикоснетесь ко рту после работы в саду, чистке лотка или прикоснетесь ко всему, что соприкасалось с инфицированными кошачьими фекалиями.
 Кошки, которые охотятся или которых кормят сырым мясом, чаще всего являются носителями T. gondii .
Кошки, которые охотятся или которых кормят сырым мясом, чаще всего являются носителями T. gondii . - Ешьте или пейте зараженную пищу или воду. Баранина, свинина и оленина особенно подвержены заражению T. gondii . Иногда непастеризованные молочные продукты также могут содержать паразита.Вода, зараженная T. gondii , не является обычным явлением в Соединенных Штатах.
- Используйте зараженные ножи, разделочные доски или другую посуду. Кухонная утварь, соприкасающаяся с сырым мясом, может содержать паразитов, если только посуда не будет тщательно вымыта в горячей мыльной воде.
- Ешьте немытые фрукты и овощи. Поверхность фруктов и овощей может содержать паразита. На всякий случай тщательно мойте и очищайте все продукты, особенно те, которые вы едите сырыми.
- Получил инфицированный трансплантат органа или перелил кровь.
 В редких случаях токсоплазмоз может передаваться при пересадке органов или переливании крови.
В редких случаях токсоплазмоз может передаваться при пересадке органов или переливании крови.
При заражении человека T. gondii паразит образует цисты, которые могут поражать практически любую часть тела — чаще всего мозг и мышечную ткань различных органов, включая сердце.
Если вы в целом здоровы, ваша иммунная система держит паразитов под контролем.Они остаются в вашем организме в неактивном состоянии, обеспечивая вам пожизненный иммунитет, чтобы вы не могли снова заразиться паразитом. Но если ваша иммунная система ослаблена болезнью или некоторыми лекарствами, инфекция может реактивироваться, что приведет к серьезным осложнениям.
Факторы риска
Любой человек может заразиться токсоплазмозом. Паразит встречается по всему миру.
Вы подвержены риску серьезных проблем со здоровьем из-за заражения токсоплазмозом, если:
- У вас ВИЧ / СПИД .
 Многие люди с ВИЧ / СПИДом также больны токсоплазмозом, либо недавней инфекцией, либо реактивировавшейся старой инфекцией.
Многие люди с ВИЧ / СПИДом также больны токсоплазмозом, либо недавней инфекцией, либо реактивировавшейся старой инфекцией. - Вы проходите курс химиотерапии. Химиотерапия влияет на вашу иммунную систему, из-за чего вашему организму становится трудно бороться даже с незначительными инфекциями.
- Вы принимаете стероиды или другие иммунодепрессанты. Лекарства, используемые для лечения некоторых незлокачественных состояний, подавляют вашу иммунную систему и повышают вероятность развития осложнений токсоплазмоза.
Осложнения
Если у вас нормальная иммунная система, вы вряд ли столкнетесь с осложнениями токсоплазмоза, хотя у здоровых людей иногда развиваются глазные инфекции. Без лечения эти инфекции могут привести к слепоте.
Но если ваша иммунная система ослаблена, особенно в результате ВИЧ / СПИДа , токсоплазмоз может привести к судорогам и опасным для жизни заболеваниям, таким как энцефалит — серьезное инфекционное заболевание головного мозга.
У больных СПИДом невылеченный токсоплазмозный энцефалит приводит к летальному исходу.Рецидив – постоянная проблема для больных токсоплазмозом, у которых к тому же ослаблена иммунная система.
У детей с врожденным токсоплазмозом могут развиться инвалидизирующие осложнения, включая потерю слуха, умственную отсталость и слепоту.
Профилактика
Некоторые меры предосторожности могут помочь предотвратить токсоплазмоз:
- Надевайте перчатки, когда работаете в саду или обрабатываете землю. Надевайте перчатки при работе на открытом воздухе и тщательно мойте руки водой с мылом после этого.
- Не ешьте сырое или недоваренное мясо. Мясо, особенно баранина, свинина и говядина, могут содержать микроорганизмы токсоплазмы. Не пробуйте мясо, пока оно не будет полностью приготовлено. Избегайте сырого вяленого мяса.

- Тщательно вымойте кухонную утварь. После приготовления сырого мяса мойте разделочные доски, ножи и другую посуду в горячей мыльной воде, чтобы предотвратить перекрестное загрязнение других продуктов. Мойте руки после контакта с сырым мясом.
- Вымойте все фрукты и овощи. Скрабируйте свежие фрукты и овощи, особенно если вы планируете есть их сырыми. По возможности удаляйте кожуру, но только после мытья.
- Не пейте непастеризованное молоко. Непастеризованное молоко и другие молочные продукты могут содержать паразитов токсоплазмы.
- Крышка для детской песочницы. Если у вас есть песочница, накрывайте ее, когда ваши дети не играют в ней, чтобы кошки не использовали ее в качестве туалета.
Для любителей кошек
Если вы беременны или подвержены риску заражения токсоплазмозом или его осложнениями, примите следующие меры, чтобы защитить себя:
- Помогите своей кошке оставаться здоровой.
 Токсоплазмоз це: ТОКСОПЛАЗМОЗ У ДОМАШНІХ УЛЮБЛЕНЦІВ ТА НЕБЕЗПЕКА ІНВАЗІЇ ДЛЯ ВАГІТНИХ
Токсоплазмоз це: ТОКСОПЛАЗМОЗ У ДОМАШНІХ УЛЮБЛЕНЦІВ ТА НЕБЕЗПЕКА ІНВАЗІЇ ДЛЯ ВАГІТНИХ

 Не використовуйте перекис водню для дезінфекції.
Не використовуйте перекис водню для дезінфекції.
 Хорошие результаты дает массаж, лечебная физкультура, электростимуляция и другие процедуры, которые врач подбирает индивидуально.
Хорошие результаты дает массаж, лечебная физкультура, электростимуляция и другие процедуры, которые врач подбирает индивидуально.
 Информацию о подходящей температуре можно найти на сайте www.cdc.gov/toxoplasmosis/prevent.
Информацию о подходящей температуре можно найти на сайте www.cdc.gov/toxoplasmosis/prevent./GettyImages-1148113560-cae3cbe11fa144b69b85b0b32e8414d7.jpg)
 д.), чтобы избежать контакта с кошачьими фекалиями.
д.), чтобы избежать контакта с кошачьими фекалиями.
 Am J Офтальмол. 1954 г., февраль; 37 (2): 163–177. [PubMed] [Google Scholar]
Am J Офтальмол. 1954 г., февраль; 37 (2): 163–177. [PubMed] [Google Scholar] [PubMed] [Google Scholar]
[PubMed] [Google Scholar] Кинематографическое исследование Toxoplasma gondii в культурах клеток. Br J Exp патол. 1961, август; 42: 357–362. [Бесплатная статья PMC] [PubMed] [Google Scholar]
Кинематографическое исследование Toxoplasma gondii в культурах клеток. Br J Exp патол. 1961, август; 42: 357–362. [Бесплатная статья PMC] [PubMed] [Google Scholar] Паразитол рез. 1992;78(3):267–269. [PubMed] [Google Scholar]
Паразитол рез. 1992;78(3):267–269. [PubMed] [Google Scholar] J Протозол. 1984 г., май; 31 (2): 288–292. [PubMed] [Google Scholar]
J Протозол. 1984 г., май; 31 (2): 288–292. [PubMed] [Google Scholar] [Бесплатная статья PMC] [PubMed] [Google Scholar]
[Бесплатная статья PMC] [PubMed] [Google Scholar] Toxoplasma модифицирует фагосомы макрофагов путем секреции везикулярной сети, богатой поверхностными белками. Джей Селл Биол. 1986 г., сен; 103 (3): 867–874. [Бесплатная статья PMC] [PubMed] [Google Scholar]
Toxoplasma модифицирует фагосомы макрофагов путем секреции везикулярной сети, богатой поверхностными белками. Джей Селл Биол. 1986 г., сен; 103 (3): 867–874. [Бесплатная статья PMC] [PubMed] [Google Scholar] 1960, февраль; 46: 11–21. [PubMed] [Google Scholar]
1960, февраль; 46: 11–21. [PubMed] [Google Scholar] [PubMed] [Google Scholar]
[PubMed] [Google Scholar] N Engl J Med. 1974 г., 3 января; 290 (1): 1–6. [PubMed] [Google Scholar]
N Engl J Med. 1974 г., 3 января; 290 (1): 1–6. [PubMed] [Google Scholar] Сурв Офтальмол. 1988 г., январь-февраль; 32 (4): 219–238. [PubMed] [Google Scholar]
Сурв Офтальмол. 1988 г., январь-февраль; 32 (4): 219–238. [PubMed] [Google Scholar] Am J Med. 1978 г., март; 64 (3): 396–402. [PubMed] [Google Scholar]
Am J Med. 1978 г., март; 64 (3): 396–402. [PubMed] [Google Scholar] Заразить иммун. 1986 г., январь; 51 (1): 147–156. [Бесплатная статья PMC] [PubMed] [Google Scholar]
Заразить иммун. 1986 г., январь; 51 (1): 147–156. [Бесплатная статья PMC] [PubMed] [Google Scholar] Am J Офтальмол. 1980 г., февраль; 89 (2): 173–179. [PubMed] [Google Scholar]
Am J Офтальмол. 1980 г., февраль; 89 (2): 173–179. [PubMed] [Google Scholar] Библ Офтальмол. 1962; 59: 265–343. [PubMed] [Google Scholar]
Библ Офтальмол. 1962; 59: 265–343. [PubMed] [Google Scholar] , Jr Острый односторонний токсоплазматический иридоциклит у больного СПИДом. Am J Офтальмол. 1988 г., 15 декабря; 106 (6): 740–741. [PubMed] [Google Scholar]
, Jr Острый односторонний токсоплазматический иридоциклит у больного СПИДом. Am J Офтальмол. 1988 г., 15 декабря; 106 (6): 740–741. [PubMed] [Google Scholar] [PubMed] [Google Scholar]
[PubMed] [Google Scholar] J заразить Dis. 1987 г., март; 155 (3): 550–557. [PubMed] [Google Scholar]
J заразить Dis. 1987 г., март; 155 (3): 550–557. [PubMed] [Google Scholar] Глазной токсоплазмоз у больных с синдромом приобретенного иммунодефицита. Am J Офтальмол. 1988 г., 15 декабря; 106 (6): 653–667. [PubMed] [Google Scholar]
Глазной токсоплазмоз у больных с синдромом приобретенного иммунодефицита. Am J Офтальмол. 1988 г., 15 декабря; 106 (6): 653–667. [PubMed] [Google Scholar]

 gondii .[5]
gondii .[5]
 gondii ДНК можно обнаружить с помощью полимеразной цепной реакции (ПЦР) в крови и других жидкостях организма.
gondii ДНК можно обнаружить с помощью полимеразной цепной реакции (ПЦР) в крови и других жидкостях организма.

 Кошки, которые охотятся или которых кормят сырым мясом, чаще всего являются носителями T. gondii .
Кошки, которые охотятся или которых кормят сырым мясом, чаще всего являются носителями T. gondii . В редких случаях токсоплазмоз может передаваться при пересадке органов или переливании крови.
В редких случаях токсоплазмоз может передаваться при пересадке органов или переливании крови. Многие люди с ВИЧ / СПИДом также больны токсоплазмозом, либо недавней инфекцией, либо реактивировавшейся старой инфекцией.
Многие люди с ВИЧ / СПИДом также больны токсоплазмозом, либо недавней инфекцией, либо реактивировавшейся старой инфекцией.
